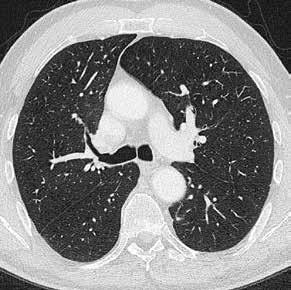
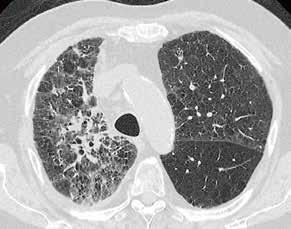
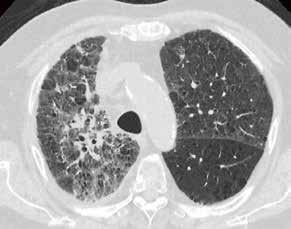

NR. 31 // AUSGABE 08/2021 // MAGAZIN FÜR MEDIZINTECHNIK Hochauflösender Ultraschall in der Sportpraxis 46 // Ultraschall: Gelenkerkrankungen im Kindesalter 64 // 56 //
intelligent
für MR 38 // Roboterbasiertes Röntgen im Klinikum Fürth VISIONS 31 // 1
Advanced
Clear-IQ Engine AiCE
Advanced intelligent Clear-IQ Engine AiCE für MR
VISIONS ist ein kostenloses Magazin von Canon Medical Systems GmbH für Berufsgruppen im Bereich Medizin und Gesundheitswesen. Es erscheint zweimal jährlich. Die Registrierung für den Erhalt vollständiger früherer digitaler Ausgaben ist über unsere Website möglich.
Für den Versand des Magazins sowie zur Information der Mitglieder über neue Entwicklungen speichert und verarbeitet Canon Medical personenbezogene Daten nach der Registrierung. Mitglieder können in ihrem VISIONSOnlineprofil Einstellungen anpassen oder sich abmelden.

VISIONS berichtet über Canon Medical in Deuschland und befasst sich daher mit Produkten, Technologien und Dienstleistungen für diese Region. Die vorgestellten Produkte sind in anderen Regionen möglicherweise nicht erhältlich. Bei Fragen wenden Sie sich bitte an Ihre örtlichen Vertretung von Canon Medical Systems GmbH.
Die Vervielfältigung dieser Publikation, deren Speicherung oder Abruf in einem automatischen System sowie die Übertragung jedweder Art sind weder ganz noch teilweise zulässig, es sei denn, es liegt die schriftliche Genehmigung des Herausgebers vor. Die enthaltenen Beiträge geben lediglich die Meinung des jeweiligen Autors wieder und entsprechen nicht unbedingt der Auffassung von Canon Medical.
Canon Medical übernimmt keine Gewähr für die Richtigkeit und Zuverlässigkeit der enthaltenen Informationen.
Aquilion ONE, Aquilion ONE / ViSION Edition, Aquilion PRIME, Aquilion ONE GENESIS Edition, Celesteion, Aquilion Prime SP, Aquilion CXL, Aquilion RXL, Infinix-i 4D CT, Infinix-i Hybrid +, Vantage Galan 3T, FIRST, PUREViSION Optics, AIDR 3D, Aplio i-series, Aplio i800, sind Warenzeichen der Canon Medical Systems Corporation. Secondlife ist Warenzeichen der Canon Medical Systems Europe B.V.
VISIONS
Magazin für Medizintechnik. Namentlich gekennzeichnete Beiträge geben nicht unbedingt die Meinung der Redaktion wieder.
Herausgeber, Redaktion und Autoren übernehmen keine Haftung für Druckfehler.
Visions 31, Ausgabe 8/2021, 1. Auflage
Herausgeber:
Canon Medical Systems GmbH, Hansemannstraße 674, 41468 Neuss
Verantwortlich für den redaktionellen Inhalt:
Stefan Pehn, Canon Medical Systems GmbH
Layout und Gestaltung: bruchhaus werbeagentur, Solingen

Druck und Verarbeitung:

Druckhaus Fischer GmbH, Haan
Fotos:
S. 1: anttoniart/Adobe Stock
S. 6: VanHope/Adobe Stock
S. 74: WavebreakmediaMicro/Adobe Stock
© 2021 by Canon. Alle Rechte vorbehalten.
Follow us:
2 // VISIONS 31
Liebe Leserin, lieber Leser,
ich freue mich, Ihnen auch in dieser Ausgabe unseres Magazins „Visions“ erneut viele interessante Themen und Artikel aus dem spannenden Umfeld der bildgebenden Diagnostik vorstellen zu können.
Als einer der Pioniere der Implementation der Künstlichen Intelligenz in die Medizintechnik, dreht sich auch in dieser aktuellen Ausgabe viel um das Thema „AiCE“, unserer Technologie für Deep Learning und neuronale Netzwerke. Wir können mit angemessenem Stolz behaupten, dass wir in dieser neuen Ära der Bildgebung nicht nur angekommen sind, sondern dass wir die Künstliche Intelligenz für Sie und Ihre Patienten bereits nutzbar machen.
Vor allem bedanke ich an dieser Stelle aber ganz herzlich bei allen unseren Kunden für die außergewöhnliche Unterstützung bei der Erstellung der Artikel und Beiträge. Nur durch die hervorragende Zusammenarbeit mit Ihnen sind wir in der Lage, die hohe Qualität der Inhalte zu gewährleisten und allen Lesern eine außergewöhnliche Lektüre zu bieten. Spannende und interessante Berichte über den Einsatz von Canon-Systemen in den Bereichen CT, MRT, Angiographie und Ultraschall bieten Ihnen einen Einblick in das umfangreiche Produktportfolio und wie unsere Kunden und Anwender dieses erfolgreich einsetzen.

Ich wünsche Ihnen viel Freude mit der vorliegenden Ausgabe.
Herzlichst
JÜRGEN FAUST
Geschäftsführer
Canon Medical Systems GmbH

VISIONS 31 // 3
//
EDITORIAL
© 2021 C ANON MEDICAL SYSTEM S



// INHALT 16 Dosisreduktion durch AiCE/ Volumendatensatz akquirieren beim Felsenbein-CT und -CCT COMPUTERTOMOGRAPHI 20 Weniger Dosis und bessere Bilder: AiCE im Bereich der Thorax- und Abdomendiagnostik COMPUTERTOMOGRAPHIE 03 Editorial 06 Aquilion Exceed LB COMPUTERTOMOGRAPHIE 12 Fundamental neue Rekonstruktionstechnologie –KI und Deep Learning in der CT COMPUTERTOMOGRAPHIE 16 Dosisreduktion durch AiCE/ Volumendatensatz akquirieren beim Felsenbein-CT und -CCT COMPUTERTOMOGRAPHIE 20 Weniger Dosis und bessere Bilder: AiCE im Bereich der Thorax- und Abdomendiagnostik COMPUTERTOMOGRAPHIE 26 Deep Learning wurde zum Standard COMPUTERTOMOGRAPHIE 34 Gehirnblutung oder Gefäßverschluss COMPUTERTOMOGRAPHIE 38 Advanced intelligent Clear-IQ Engine AiCE für MR MAGNETRESONANZTOMOGRAPHIE 06 Aquilion Exceed LB COMPUTERTOMOGRAPHIE 4 // VISIONS 31
64 Gelenkerkrankungen im Kindesalter
ULTRASCHALL
46
Roboterbasiertes Röntgen im Klinikum Fürth

X-RAY
56
Hochauflösender Ultraschall in der Sportpraxis

ULTRASCHALL
46 Roboterbasiertes Röntgen im Klinikum Fürth
X-RAY
52 Neuartige High-Defintion-Technologie: „Wie ein Mikroskop für den Neuroradiologen“
X-RAY
56 Hochauflösender Ultraschall in der Sportpraxis
ULTRASCHALL
60 Ein Plädoyer für hochwertige Ultraschallausrüstung in der neurologischen Praxis

ULTRASCHALL
63 Veranstaltungen & Workshops 2021/22
64 Gelenkerkrankungen im Kindesalter
ULTRASCHALL
68 Traumatische Nervenläsionen –über den Einsatz des Nervenultraschalls
ULTRASCHALL
VISIONS 31 // 5 © 2021 C ANON MEDICAL SYSTEM S

6 // VISIONS 31
Wahre Größe
Die weltweit größte Gantryöffnung des neuen Aquilion Exceed LB CTs sowie der Einsatz von KI setzen neue Standards in der TraumaCT wie für den Scan adipöser Patienten. Die 90 cm Gantrydurchmesser sind ein herausragendes Merkmal, das abteilungsübergreifend Patienten und Anwendern wirklichen Mehrwert bringt. Die künstliche Intelligenz ist bei der neuen AiCE-Deep-LearningRekonstruktionstechnologie angekommen.

Der brandneue Computertomograph Aquilion Exceed LB von Canon Medical ist ein Multitalent mit wahrer Größe. Natürlich profitieren natürlich adipöse Patienten vom Freiraum während der Untersuchung. Die Buchstaben „LB“ im Namen stehen für „Large Bore“ und beschreiben die weltweit größte Gantryöffnung von 90 cm. Dabei wurde der Aquilion Exceed LB sowohl für Universitätskliniken entwickelt, die auf höchstem Niveau arbeiten, als auch für große, mittlere und spezialisierte Institute, die besonderen Wert auf eine große Gantryöffnung legen.
Der perfekte Trauma-CT
Der neue Aquilion Exceed LB verfügt mit 90 cm Durchmesser über die größte Gantryöffnung in der Computertomographie. Er bietet so den Mitarbeitern wie den Patienten maximalen Raum während der CTUntersuchung. Patienten können „Feetfirst“ gelagert werden, so dass sie gar nicht oder nur kurz mit dem Kopf durch die Gantry gefahren werden müssen. Der neu entwickelte BigBore80ZeilenCTDetektor sowie die gesteigerte Rotationsgeschwindigkeit sind die Garantie für kurze Untersuchungszeiten. Die neue Rekonstruktionshardware überwindet bisherige Limitationen
TECHNOLOGIE // COMPUTERTOMOGRAPHIE // AQUILION EXCEED LB VISIONS 31 // 7 © 2021 C ANON MEDICAL SYSTEM S
85 mm 85 mm
Die laterale Verschiebung der Patientenliege stellt die mittige Positionierung des Patienten im Iso-Center sicher, auch wenn er zuvor exzentrisch gelagert wurde. Insbesondere für Trauma-, Intensiv- und adipöse Patienten ist dieses Feature von besonderem Vorteil.
in puncto Geschwindigkeit. Bis zu 70 ultrahochauflösende 0,5mmDünnschichtbilder pro Sekunde sind mit dem neuen System rekonstruierbar. Automatische mittige Patientenpositionierung, keine Patientenumlagerung mehr
Die SurePositionTechnologie positioniert den Patienten automatisch im Isozentrum, sowohl die Höhe als auch die laterale Position können angepasst werden. So müssen Patienten nicht mehr nachträglich umgelagert werden, insbesondere bei traumatisierten oder
narkotisierten Patienten ist dieses Feature eine große Arbeitserleichterung für die Mitarbeiter. Außerdem ermöglicht es das ergonomische Arbeiten am CT. Die neue Geometrie des Aquilion Exceed LB sichert Untersuchungen bis zu einem Patientengewicht von 315 kg bei einer maximalen Scanlänge von 2 m.

KI optimiert die Bildgebung mit neuer Deep-Learning-Rekonstruktion
Leistungsstarke KIbasierte Rekonstruktionstechnologien machen das „Megathema künstliche Intelligenz“ anwendbar und klinisch nutzbar. Mit der neuen DeepLearningRekonstruktion AiCE (Advanced Image Clear IQ Engine) erreicht der neue Aquilion Exceed LB die Epoche der künstlichen Intelligenz. Der AiCE hebt die Bildqualität in der Computertomographie auf ein ganz neues Niveau und reduziert dabei zusätzlich die Dosis.
Die Deep-Learning-Rekonstruktion AiCE ist für neuronale und karidiale Bereiche sowie für Abdomen, Knochen und Lunge verfügbar.

AiCE, die Advanced Intelligent Clear IQ Engine, stellt einen Paradigmenwechsel in der Bildrekonstruktionstechnologie dar und nutzt ein trainiertes neuronales Netzwerk, um schärfere, klarere und damit eindeutigere Schichtbilder zu erhalten. Das neuronale Netz in AiCE ist darauf trainiert, Bilder so zu rekonstruieren, dass sie der räumlichen Auflösung und den rauscharmen Eigenschaften einer modernen modellbasierten iterativen Rekonstruktion (MBIR) entsprechen. Das erlernte Wissen wird in verschiedenen Layern (Input, Hidden und OutputLayern) des neuronalen Netzwerks angewendet. Die Anwendung dieses Wissens bei der Bildrekonstruktion macht AiCE außerordentlich effizient, wenn es darum geht, bei CTUntersuchungen routinemäßig eine hohe räumliche Auflösung und ein geringes Rauschen zu erzielen. Dies trägt maßgeblich dazu bei, das diagnostische Vertrauen zu verbessern. AiCE ist in die Belichtungsautomatik SureExposure 3D integriert und gewährleistet eine 8 // VISIONS 31
automatische Dosisreduzierung von bis zu 82 %; dabei erreicht AiCE einen bis zu 14 % besseren Niedrigkontrast als AIDR 3D, z. B. bei AbdomenCTs mit gleicher Dosis.
Metallartefaktreduktion serienmäßig

Mit SEMAR, der iterativen Metallartefaktreduzierung, können sogar schwierige Untersuchungen, z. B. mit Zahnfüllungen, Wirbelsäulenimplantaten, beidseitigen Hüftimplantaten, NeuroCoils und Schrittmachern durch einen flexiblen und reibungslosen Arbeitsablauf sicher ausgewertet werden. Der SingleEnergyMetallArtefaktReduktionsalgorithmus beinhaltet zwei erfolgreiche Ansätze zur Reduzierung von Metallartefakten: Er kombiniert eine Strahlaufhärtungskorrektur mit dem IterationsHybridverfahren AIDR 3D Enhanced, um die Rauschtextur und scharfe Details neben Metallen wiederherzustellen. Dieser Prozess wird Schicht für Schicht über den gesamten Untersuchungsbereich durchgeführt, was in kürzester Zeit zu einem Artefaktfreien diagnostischen Bildstapel führt. SEMAR kann sowohl in schon hinterlegten, standardisierten Protokollen genutzt oder alternativ im Postprocessing über die Rohdaten ausgewählt und angewendet werden.
Perfekter CT für die Untersuchung besonders adipöser Patienten




Die Patienten liegen bequem auf der besonders ergonomischen Patientenliege mit 47 cm Breite. Um den Zugang zu erleichtern, lässt sich die Liege auf 31 cm absenken. Sowohl Patienten, die aus dem Rollstuhl auf die CTLiege umgelagert werden müssen, als auch das Personal profitieren von diesem Detail sehr.
Schnellere Scans stellen sowohl die 80 Zeilen sicher als auch die schnellere Rekonstruktion mittels neuer Hoch
leistungshardware. Gleichzeitig werden die 0,5 mm dünnen Schichten beibehalten. Dank der höheren Scangeschwindigkeit steigt der Patientenkomfort und somit auch die Patientenzufriedenheit. Die Verbreiterung des Detektors auf 80 Zeilen und die Erhöhung der Rotationsgeschwindigkeit auf 400 Millisekunden pro Rotation sind die Grundlage für die neue erhöhte Scangeschwindigkeit. Damit ist der Scan auch robuster gegen unerwünschte Patientenbewegungen, was wiederum die Notwendigkeit einer zweiten Untersuchung reduzieren kann.
Vergleich der Rekonstruktionstechnologien: 0,5-mm-Schichten rekonstruiert durch die herkömmliche gefilterte Rückprojektion (FBP), die hybrid-iterative Rekonstruktion AiDR 3D und die neue Deep-Learning-Rekonstruktion AiCE.
Auch für bildgesteuerte Interventionen bietet der neue LB-CT viel Raum – sehr viel Raum.
0,5 mm AIDR 3D 0,5 mm AiCE 0,5 mm FBP VISIONS 31 // 9 © 2021 C ANON MEDICAL SYSTEM S
Dual-Energy-Spezialuntersuchungen
DualEnergyScans führt der neue CT sequentiell oder aus der Spirale heraus durch. Umfangreiche Softwarepakete, z. B. für die Nierensteinanalyse, die Gichtanalyse, IodineMaps, Blending und Enhanced Images sowie zur Bestimmung der Elektronendichte stehen zur Verfügung.
Dabei ist der neue Aquilion Exceed LB gleichermaßen ein besonders leistungsfähiges 80Zeilen/160SchichtSystem für alle täglichen Routinearbeiten und eine effiziente Plattform, die einen wirtschaftlichen CTBetrieb sichert. Mit seiner Vielzahl an klinischen Applikationen unter Anwendung der neusten LowDoseTechnologien ist der Aquilion Exceed LB Computertomograph DAS neue System für Routineund Spezialanwendungen.
Intuitiver Workflow

Auch wenig geübte Anwender oder Mitarbeiter, die häufig wechseln, werden mit dem Aquilion Exceed LB mit Leichtigkeit arbeiten können. Der Workflow wird optimal durch voll automatisierte Prozesse unterstützt, z. B. durch bis zu 70 vordefinierte Autorekonstruktionen inklusive des sich anschließenden Bildtransfers. //
Die SEMAR-Metallartefaktreduktion minimiert die durch Implantate verursachten Bildstörungen und sichert so die Diagnostik sowohl des Metalls selbst wie auch des umliegenden Gewebes.
Auch die Untersuchung von besonders adipösen Patienten ist mit dem neuen Large Bore CT leicht möglich. Bis zu 315 kg Patientengewicht trägt die CT- Liege, die auch für Ganzkörper-CTs bis zu 200 cm flexibel einsetzbar ist.




NEU
Der neue Aquilion Exceed Large Bore CT von Canon Medical Systems.
Original
SEMAR
10 // VISIONS 31
Rapid kV, Deep Learning, Spectral Imaging




Der neue Aquilion ONE PRISM von Canon Medical Systems wurde entwickelt, um Ihre Schnittbildgebung auf ein völlig neues diagnostisches Level zu heben. Dieser 320-ZeilenVolumen-CT nutzt nicht nur die zeitlichen Vorteile einer schnellen kV-Umschaltung mit patientenspezifischer mA-Modulation, sondern kombiniert sie auch mit dem Einsatz eines Deep-Learning Rekonstruktions-Algorithmus, der eine hervorragende Energietrennung und rauscharme Eigenschaften in der Bildqualität bietet.

Virtual Non Contrast Monochromatic Iodine map with fusion https://de.medical.canon
Fundamental neue
Rekonstruktionstechnologie –KI und Deep Learning in der CT

Die Ansprüche steigen und die Radiologie wird komplexer – immer mehr ist in immer kürzerer Zeit zu bewältigen. Die richtige und sichere Diagnose ist und bleibt der Schlüssel für die weitere Behandlung der Patienten. Dabei profitieren RadiologInnen von neuester Technologie, die sie in der Klinik unterstützt.
Auf den folgenden Seiten lesen Sie Berichte namhafter Anwender der neuesten Rekonstruktionstechnologie „AiCE“ (Advanced intelligent Clear Image Quality Engine) von Canon Medical, die heute bereits zur Verfügung steht. Damit sind wir im Zeitalter der künstlichen Intelligenz nicht nur angekommen, wir machen sie nutzbar – zum Vorteil für RadiologInnen und PatientInnen.
EINLEITUNG // COMPUTED TOMOGRAPHY // KI, AiCE
12 // VISIONS 31
Technischer Hintergrund
Das Selbstlernen der Software und Deep Learning, das Lernen mittels eines neuronalen Netzwerkes, sind Teilbereiche der künstlichen Intelligenz und Megathemen der Radiologie. Canon Medical hat kürzlich die neue „AiCE“Technologie vorgestellt, die auf diesen Megathemen basiert und die CTBildrekonstruktion der Zukunft schon heute anwendet. Neue Canon CTs können bereits heute von dieser Technologie profitieren.
Die neue KI-Technologie „AiCE“ bietet eine fundamental neue Bildrekonstruktion mit überragender Bildqualität, einer bis dahin nicht erreichten Detailschärfe und einem natürlichen Bildkontrast – schon ab einer Schichtdicke von 0,5 mm.
Dabei reduziert AiCE das Rauschen bei gleichzeitigem Erhalt der Textur und des natürlichen Bildeindruckes. AiCE lässt somit Ihre Patienten von einer bis dato nicht erreichten Dosisreduktion und Sie als Radiologen von einer gesteigerten Sicherheit bei der Diagnostik von Dünnschichtbildern profitieren.
AiCE basiert auf den Megathemen der Softwareentwicklung und setzt in der radiologischen Diagnostik neue Maßstäbe. Die Megathemen sind: Big Data: das Einspeisen von sehr großen Datenmengen in Form tausender Datensätze, Deep Learning: das Lernen mittels eines neuronalen Netzwerkes, und künstliche Intelligenz: das Selbstlernen der Software
Während die Rekonstruktion mittels der neuesten modellbasierten iterativen Rekonstruktion noch ein sehr rechenaufwändiger Prozess war, der mehr Zeit in Anspruch nahm und daher überwiegend selektiv eingesetzt wurde, arbeitet die neue AiCERekonstruktion von Canon Medical annähernd so schnell wie die bekannte iterative Rekonstruktion und ist damit in der klinischen Routine einsetzbar.
Damit RadiologInnen in ihrer Umgebung – im Rahmen ihrer klinischen Routine – mit AiCE arbeiten können, wurden zwei Schritte vorbereitet. Im Canon Medical Systems Werk wurde

in Schritt I das neuronale Netzwerk mittels einer besonderen Hochleistungshardware aufgesetzt; es wurde ein sog. „Neural Network Training“ mit Tausenden von validierten Datensätzen durchgeführt. Dieses im Werk trainierte neuronale Netzwerk wird in Schritt II beim Kunden auf einer eigenen Hochleistungshardware installiert. Die beim Radiologen vor Ort gescannten Daten werden mittels AiCE rekonstruiert und stehen der Befundung in beeindruckender Geschwindigkeit unmittelbar zur Verfügung.
Der Trainingsprozess des neuronalen Netzwerkes ist rechnerisch sehr aufwändig: Der Massendatenspeicher „Big Data“ wurde mit zwei Arten von Datenmengen gespeist: mit einer Vielzahl hochqualitativer Datensätze, die zuvor mittels modellbasierter Iteration in den Rohdaten mit überproportional häufigen Iterationen und deutlich erhöhter Rechenleistung rekonstruiert wurden, und mit einer Vielzahl von UltraLowDoseDatensätzen, wie sie in der täglichen Routine bei Niedrigdosisuntersuchungen vorkommen.
VISIONS 31 // 13 © 2021 C ANON MEDICAL SYSTEM S
Training AiCE – Deep Learning
Network Training
AiCE – Validated Deep Convolutional Neural Network
Eine Software mit einem „Deep Convolution Neural Network“ wurde angelernt, Organstrukturen voxelgenau im menschlichen Körper zu erkennen –das neuronale Netzwerk weiß nach dem Trainingsprozess, welche Zusammenhänge zwischen Low-Dose-Datensätzen und hochqualitativen Datensätzen bestehen – dieses Wissen dient der Rekonstruktion von Low-Dose-Datensätzen zu einem perfekten diagnostischen Bild.
AiCE-Deep-Learning-Rekonstruktion für verschiedene Körperregionen.


Low-quality Input Data Multiple Variations Scanner model Anatomical model Optics model High-quality Target Advanced MBIR Physical model Statistical model Data Acquisition
AiCE Image 14 // VISIONS 31
Lernprozess AiCE
Für den Trainingsprozess wurden reale Patientendaten bzw. Schichtbilder unterschiedlicher Körperregionen, die mit unterschiedlichen Bildqualitäten und Rekonstruktionskernels rekonstruiert wurden, in einer Datenbank zusammengestellt.
Aus den rekonstruierten Schichtbildern werden „Patches“ (Fragmente) besonderer Strukturen ausgeschnitten und als mathematische Matrizen verarbeitet. Diese Matrizen werden anhand der HUWerte in den Schichtbildern parametrisiert. Mathematische Operationen der Patches werden auf Pixelebene mittels Faltung (Convolution) durchgeführt, bei ausreichender Wiederholung von Faltungen (Convolutionen) spricht man von einem Deep Convolutional Neural Network.
Die Matrizen werden zu künstlichen Neuronen verschaltet, die über mehrere Eingänge und einen Ausgang verfügen; der Ausgang reagiert auf die Gewichtungen der Eingänge der Neuronen.
Die Neuronen sind in mehreren „Layern“ (Schichten) organisiert, die Signale werden durch die Layer „propagiert“. Vom Eingangslayer über mehrere Zwischenlayer bis zum Ausgangslayer sind immer die Ausgänge der einzelnen Neuronen mit neuen Eingängen der nächsten Neuronen verbunden. Jedes Neuron in einem neuronalen Netzwerk berechnet einen Ausgabewert, indem eine bestimmte Funktion auf die Eingabewerte angewendet wird, die von dem vorherigen Layer stammen. Die Funktion, die auf die Eingabewerte angewendet wird, bestimmt die Gewichtungen. Das Lernen in einem neuronalen Netzwerk schreitet voran, indem iterative Anpassungen an den Gewichtungen vorgenommen werden.
Nach der Propagation findet eine Prüfung des neuronalen Netzes statt, die sog. Backpropagation. Dafür wird die Ausgabe des neuronalen Netzes mit dem erwarteten bzw. bekannten Ergebnis verglichen und eine Abweichung ermittelt. Die Abweichung wird
nun vom Ausgabelayer zum Eingabelayer zurückgegeben (Backpropagation).
Um die Abweichungen zu reduzieren, werden die Gewichtungen der Neuronen angepasst, mit jeder Anpassung wird das neuronale Netz optimiert. //
Literatur
Boedecker K. AiCE Deep Learning Reconstruction: Bringing the power of Ultra-High Resolution CT to routine imaging. 2019

Akagi M, Nakamura Y, Higaki T et al: Deep learning reconstruction improves image quality of abdominal ultra-high-resolution CT. Eur Radiol 2019; 29: 6163–6171
Nakamura Y, Higaki T, Tatsugami F et al: Deep Learning-based CT Image Reconstruction: Initial Evaluation Targeting Hypovascular Hepatic Metastases. Radiology: Artificial Intelligence 2019; 1: e180011
Higaki T, Nakamura Y, Zhou J et al: Deep Learning
Reconstruction at CT: Phantom Study of the Image Characteristics. Academic Radiology 2020; 27: 82-87
Narita K, Nakamura Y, Higaki T et al: Deep learning reconstruction of drip-infusion cholangiography acquired with ultra-high-resolution computed tomography. Abdom Radiol 2020.
VISIONS 31 // 15 © 2021 C ANON MEDICAL SYSTEM S

TECHNOLOGIE // COMPUTERTOMOGRAPHIE // Dosisreduktion durch AiCE 16 // VISIONS 31
Dosisreduktion
durch AiCE/ Volumendatensatz akquirieren beim Felsenbein-CT und -CCT.
Durch die Einführung des neuen Canon CT Aquillion One Genesis im Institut für Diagnostische und Interventionelle Neuroradiologie an der Medizinischen Hochschule Hannover (MHH) ist es nun möglich, mittels Volumenscan Körperbereiche von bis zu 16 cm Scanlänge in einer Rotation zu akquirieren. Dies brachte nicht nur deutliche Vorteile in der Ganzhirnperfusion bei der akuten Schlaganfallversorgung, sondern auch eine erhebliche Reduktion von Bewegungsartefakten durch die minimalste Scanzeit von 0,275 Sekunden!
Dadurch minimierten sich Wiederholungen von CT-Untersuchungen bei unruhigen/nicht kooperativen Patienten. Speziell bei Kindern kann nun durch die schnelle Scanzeit häufiger auf eine Sedierung/ Intubationsnarkose verzichtet werden.
Auch die HNO-Bildgebung, die in der MHH einen großen Stellenwert einnimmt, war bei jungen Patienten nur eingeschränkt möglich, da die CT-Aufnahme des Felsenbeins/der Schädelbasis ca. 5–7 Sekunden Akquirierungszeit und am DVT (Cone Beam CT) eine Aufnahme ca. 20 Sekunden erfordert.

Ein weiterer Nachteil des DVT ist der Aufbau des Gerätes an sich. Durch die sitzende Haltung und die stark eingeschränkten Möglichkeiten der individuellen Anpassung war es meist nur möglich, Kinder ab fünf Jahren zu untersuchen.
Mit dem vorbestehenden CT hat sich bei CT-Scans die Zeit proportional zum eingestellten Scanbereich erhöht. Bei individuellen Anpassungen des Scanbereiches gab es entsprechend eine Erhöhung der Scanzeit, was dann auch das Risiko der Bewegungsartefakte erhöhte.
Dr. Paul Bronzlik (l.), Oberarzt, und Prof. Dr. Heinrich Lanfermann (r.), Institutsdirektor am Institut für Diagnostische und Interventionelle Neuroradiologie, Medizinische Hochschule Hannover
VISIONS 31 // 17 © 2021 C ANON MEDICAL SYSTEM S
Mit dem Volumenscan besteht nun die Möglichkeit, einen Bereich von 16 cm Länge mittels einer Röhrenrotation darzustellen. Dieser Bereich ist individuell anpassbar in 2-cm-Schritten, womit befundorientiert unter Beachtung des Strahlenschutzes der Untersuchungsbereich eingegrenzt werden kann. Die Untersuchungszeit ist gleichbleibend niedrig, unabhängig von der gewählten Scanlänge (2–16 cm).
Die HNO-Klinik der Medizinischen Hochschule Hannover setzt ca. 500 Cochlea-Implantate ein, womit sie aktuell weltweit den Spitzenreiter darstellt. Für die OP-Planung ist eine sehr gute örtliche Auflösung und ein starker Kontrast des Felsenbeins erforderlich, um dem Operateur, der die Elektrode in die Schnecke das Runde Fenster zielgenau einführen muss, eine gute Planungsgrundlage zu schaffen. Auch muss post die intracochleare Lage kon werden, was technisch eine große Herausforderung darstellt, da die Strukturen in diesem Areal sehr fein sind und durch das implantierte Metall Aufhärtungsartefakte ent die Diagnostik dadurch erschweren.
Goldstandard war bis dato das DVT, das durch die Cone Beam Technik stark reduzierte Aufhärtungsartefakte aufwies und somit genaue Aussagen zwecks Lagekontrolle liefern konnte. Es kommt jedoch für einen Großteil der Patienten (Kinder 1–5) aufgrund der vorher erwähnten Gründe nicht in Frage. Ein großer Vorteil des neuen Canon CTs ist die bereits gut etablierte Metallartefakt-Reduktion SEMAR,die durch Algorithmen die Artefakte stark reduzieren kann. Es entsteht dadurch


keine wesentliche Einschränkung zur Identifizierung der ersten Kontaktelektrode im Vergleich zum DVT.
Auch der neuentwickelte Deep Learning Algorithmus AiCE des Canon Aquilion ermöglicht die Reduktion der Dosis, bei gleichbleibendem bzw. verbessertem Bildeindruck. AiCE bietet zudem eine scharfe Abgrenzung feiner Strukturen und reduziert das durch Low-DoseTechnik auftretende Rauschen. //
18 // VISIONS 31
2. Vergleich eines cranialen CTs mit und ohne Deep Learning Rekonstruktion AiCE:




CTDI





30,2 mGy 544,6 mGy*cm

Felsenbein-CT Felsenbein CT-Rekonstruktion
Elektrode
CCT AIDR
der
Felsenbein-DVT
CCT AiCE
Vergleich
DVT: CDTI DLP Volumen-CT 6,5 mGy 39 mGy*cm DVT 7,3 mGy 76,6 mGy*cm Vorgänger-CT 17,1 mGy 176 mGy*cm CT vs. DVT
„AiCE unterstützt die Diagnosefindung in der Neuroradiologie dank der sofort sichtbar besseren Bildqualität bei gleicher Dosis.“
1.
einer Felsenbeinaufnahme, CT vs.
VISIONS 31 // 19 © 2021 C ANON MEDICAL SYSTEM S
DLP
Dosis
Clemenshospital

Düesbergweg 124, 48153 Münster
Raphaelsklinik
Loerstr. 23, 48143 Münster
20 // VISIONS 31
Weniger Dosis und bessere Bilder: AiCE im Bereich der Thorax- und Abdomendiagnostik
Als im Clemenshospital Münster die Entscheidung zur Anschaffung eines zweiten CT-Scanners getroffen werden sollte, fiel die Wahl schnell auf den Canon CT Aquilion Prime SP, insbesondere da zuvor schon lange gute Erfahrungen mit dem Betrieb des Canon Aquilion ONE gemacht worden waren.

Als dann kurz darauf noch AiCE nachgerüstet wurde, stieg der Wert der Investition durch die Möglichkeiten der Dosisreduktion und Bildqualitätsverbesserung nochmals an. In vielen Bereichen der CT-Diagnostik sind die neuen, KI-basierten Rekonstruktionen im Clemenshospital nun fester Bestandteil der Standardprotokolle. Vor allem die rasche Implementierung und der nur wenig größere
Zeitaufwand für die Bildrekonstruktion fielen hierbei äußerst positiv auf. Der Mehrwert lässt sich leicht anhand einiger Beispiele aus dem klinischen Alltag belegen. Zusammenfassend bieten sich mit AiCE deutliche Vorteile: zum einen bei der Bildqualität und somit auf dem Weg zur richtigen Diagnose zum anderen durch die Dosisreduktion auch im Bereich der Patientensicherheit.
TECHNOLOGIE // COMPUTERTOMOGRAPHIE // Dosisreduktion durch AiCE
VISIONS 31 // 21 © 2021 C ANON MEDICAL SYSTEM S
Prof. Dr. med. Johannes Weßling Chefarzt, Zentrumsleiter Zentrum für Radiologie, Neuroradiologie und Nuklearmedizin
Fall 1:
Biphasische Abdomen-CT bei einer deutlich adipösen Patientin. Hier lässt sich sowohl Dosis sparen als auch die Qualität der Rekonstruktionen verbessern. Beispielsweise findet sich deutlich weniger Bildrauschen, insbesondere im Bereich der parenchymatösen
Fall 2:
Portalvenöse Abdomen-CT. Auch hier ist die Dosis am Aquilion Prime SP mit AiCE geringer, zudem auch hier geringeres Bildrauschen mit sehr guter Abgrenzbarkeit, beispielsweise von Leberläsionen.





 Abb. 1 a: biphasische Abdomen-CT, Canon Aquilion Prime, Rekonstruktion: AIDR 3D; DLP 1003,6 mGy × cm / 18,1 mSv.
Abb. 2 a: biphasische Abdomen-CT, Canon Aquilion Prime, Rekonstruktion: AIDR 3D; DLP 1003,6 mGy × cm / 18,1 mSv.
Abb. 1 b: biphasische Abdomen-CT, Canon Aquilion Prime, Rekonstruktion: AiCE; DLP 716,5 mGy × cm / 12,9 mSv.
Abb. 2 b: biphasische Abdomen-CT, Canon Aquilion Prime, Rekonstruktion: AiCE; DLP 716,5 mGy × cm / 12,9 mSv.
Oberbauchorgane.
Abb. 1 a: biphasische Abdomen-CT, Canon Aquilion Prime, Rekonstruktion: AIDR 3D; DLP 1003,6 mGy × cm / 18,1 mSv.
Abb. 2 a: biphasische Abdomen-CT, Canon Aquilion Prime, Rekonstruktion: AIDR 3D; DLP 1003,6 mGy × cm / 18,1 mSv.
Abb. 1 b: biphasische Abdomen-CT, Canon Aquilion Prime, Rekonstruktion: AiCE; DLP 716,5 mGy × cm / 12,9 mSv.
Abb. 2 b: biphasische Abdomen-CT, Canon Aquilion Prime, Rekonstruktion: AiCE; DLP 716,5 mGy × cm / 12,9 mSv.
Oberbauchorgane.
22 // VISIONS 31
Fall 3:

Thorax-CT im Rahmen einer Lungenkrebsfrüherkennungsstudie. Die Voruntersuchung lag als externe kontrastmittelgestützte Thorax-CT vor. Bei der dosisoptimierten Low-Dose-CT liegt die Strahlenexposition nur noch im Bereich von zwei konventionellen Röntgenaufnahmen des Thorax, die Bildqualität ist für die Fragestellung nach Herdbefunden aber dennoch eindeutig ausreichend, selbst interstitielle Lungenveränderungen lassen sich hier noch beurteilen.



„KI-basierten Rekonstruktionen im Clemenshospital nun fester Bestandteil der Standardprotokolle.“
Prof. Dr. med. Johannes Weßling Zentrum für Radiologie, Neuroradiologie und Nuklearmedizin
Abb. 3 a: kontrastmittelgestützte Thorax-CT, externe Untersuchung; DLP 216,0 mGy × cm / 3,9 mSv.
Abb. 3 b: dosisoptimierte Low-Dose-Thorax-CT, Canon Aquilion Prime SP, Rekonstruktion: AiCE; DLP 13,9 mGy × cm / 0,25 mSv.
VISIONS 31 // 23 © 2021 C ANON MEDICAL SYSTEM S
Low-Dose-Thorax-CT als Verlaufskontrolle bei Lungenkarzinom unter Immuntherapie. Aus der Anfangsphase der Implementierung von AiCE im klinischen Alltag zeigt sich bei vergleichbarer Dosis eine bessere Bildqualität mit besserer Detailauflösung im Bereich des Lungenparenchyms, hier im Bereich der strahligen Ausläufer des Tumors und an den direkt angrenzenden Bronchialstrukturen gut zu erkennen.




Fall 4: Fall 5:

Einer der ersten Patienten, die nach der Installation der AiCE-Algorithmen untersucht wurden. Hier wurde zum Vergleich aus derselben Untersuchung jeweils eine Rekonstruktion mittels AIDR 3D und eine Rekonstruktion mit AiCE angefertigt. Auch hier fällt die bessere Detailauflösung, beispielsweise im Bereich der Interlobulärsepten oder der Emphysembullae, auf. //
 Abb. 5 a: Low-Dose-Thorax-CT, Canon Aquilion Prime SP, Rekonstruktion: AIDR 3D; DLP 115,8 mGy × cm / 2,1 mSv
Abb. 4 a: Low-Dose-Thorax-CT, Canon Aquilion ONE, Rekonstruktion: AIDR 3D; DLP 55,1 mGy × cm / 1,0 mSv
Abb. 5 b: dieselbe Untersuchung, Rekonstruktion: AiCE
Abb. 4 b: Low-Dose-Thorax-CT, Canon Aquilion Prime SP, Rekonstruktion: AiCE; DLP 65,7 mGy × cm / 1,2 mSv
Abb. 5 a: Low-Dose-Thorax-CT, Canon Aquilion Prime SP, Rekonstruktion: AIDR 3D; DLP 115,8 mGy × cm / 2,1 mSv
Abb. 4 a: Low-Dose-Thorax-CT, Canon Aquilion ONE, Rekonstruktion: AIDR 3D; DLP 55,1 mGy × cm / 1,0 mSv
Abb. 5 b: dieselbe Untersuchung, Rekonstruktion: AiCE
Abb. 4 b: Low-Dose-Thorax-CT, Canon Aquilion Prime SP, Rekonstruktion: AiCE; DLP 65,7 mGy × cm / 1,2 mSv
24 // VISIONS 31
Die künstliche Intelligenz verändert die Radiologie.
Erleben Sie die neue Qualität der Canon MRT- und CT-Bildgebung mit künstlicher Intelligenz.
Canon Medical Systems High-End-CTs und -MRTs bieten die weltweit erste Rekonstruktion basierend auf den Megathemen „Künstliche Intelligenz“ und „Deep Learning“ und erreichen so eine völlig neue Dimension der Bildqualität. Überzeugen Sie sich selbst!

https://de.medical.canon

26 // VISIONS 31
Deep Learning wurde zum Standard

Seit Mitte 2020 arbeiten wir in unserer Abteilung mit einem VolumenCT Aquilion PRISM mit der neuen KI-Technologie „AiCE“ (Advanced intelligent Clear Image Quality Engine). Das System bietet eine fundamental neue Bildrekonstruktion mit überragender Bildqualität, einer enormen Detailschärfe und dem gewohnten Bildkontrast. Von Beginn an wurde die Deep Learning basierte Rekonstruktion (DLR) als neuer Standard festgelegt. Das bedeutet: Wann immer möglich erfolgt die Rekonstruktion mit AiCE. Nach einem Dreivierteljahr Erfahrung mit dem High-End-CT kann ich sagen:
AiCE hat eine neue Ära der Bildrekonstruktion eingeläutet, die wir nicht mehr missen möchten.
Wir hatten initial die Möglichkeit, die neue Deep-Learning-Rekonstruktion entweder für eine weitere Dosisreduktion zu nutzen oder alternativ die Bildqualität noch einmal anzuheben. Bei der Dosisreduktion waren wir mit den Canon CTs immer sehr weit vorn, in den bisherigen Untersuchungsprotokollen liegen wir teils deutlich unter den diagnostischen Referenzwerten des Bundesamtes für Strahlenschutz. Daher haben wir uns bewusst dafür
entschieden, die neue Technik für eine höhere Bildqualität zu nutzen.
Das hat sich extrem bewährt: Wir profitieren tagtäglich von einer deutlichen Aufwertung der Bilder. Diese Entscheidung für den Aquilion PRISM war auch richtig, was das Kollegium hier ebenso wertet. Am liebsten hätten wir AiCE an allen CTs verfügbar. Auch der Übergang von den bekannten Geräten zum CT Aquilion PRISM mit der AiCE-Technologie wurde von allen Mitarbeitern als angenehm empfunden. Weder muss man sich neu „einfinden“ noch neu lernen, die Bilder zu interpretieren.
TECHNOLOGIE // COMPUTERTOMOGRAPHIE // AiCE VISIONS 31 // 27 © 2021 C ANON MEDICAL SYSTEM S
Prof. Dr. med. Dr. rer. medic. Stefan M. Niehues, MHBA Leitender Oberarzt der Klinik für Radiologie Charité – Universitätsmedizin Berlin Campus Benjamin Franklin Hindenburgdamm 30, 12203 Berlin
Die Bilder sind wesentlich klarer und zeigen ein deutlich erhöhtes SignalRauschVerhältnis (SNR) mit einer deutlich besseren Abgrenzung von möglichen Prozessen als bei den herkömmlichen CTs.
Gerade das Rauschen hat noch einmal deutlich abgenommen. In der Folge fällt die Diagnosestellung leichter. Die Begeisterung teilen viele unserer Spezialisten. So erhalten wir z. B. aus der Kardiologie die Rückmeldung, dass unsere Abteilung mit dem Hightech-CT im Vergleich zu anderen radiologischen Untersuchungen die beste Bildgebung vorweisen kann. Gerade bei Fällen, wo es um kleine Strukturen geht, Beispiel „Revaskularisierung chronischer Koronarobstruktionen“: Hier gilt unsere Bildgebung für die Planung der Rekanalisationen von chronischen Koronarverschlüssen (CTO) mittlerweile als Standard. Wir bekommen aus der Kardiologie ausschließlich Lob und eine große Zufriedenheit zurückgespiegelt. Bei der Kardiodiagnostik wird der Volumen-CT absolut priorisiert.

„Wir profitieren tagtäglich von einer deutlichen Aufwertung der Bilder. Diese Entscheidung für den Aquilion PRISM war auch richtig, was das Kollegium hier ebenso wertet.“
28 // VISIONS 31
Prof. Dr. med. Dr. rer. medic. Stefan M. Niehues, MHBA
Die Herzuntersuchungen sind damit in unserer Abteilung auf einem Niveau angekommen, das – Stand heute – schwer zu toppen ist.

Die notwendige Dosis – schon beim zweiten Kardio-CT weniger als 1 Millisievert – ist durchgehend sehr gering. Dank der kurzen Scanzeit und der hohen zeitlichen Auflösung untersuchen wir heute selbst Herzen im Volumen-CT, bei denen wir früher gezögert hätten. So z. B. bei dem Fall




der 64-jährigen arrhythmisch Patientin mit V. a. KHK (Fall Nr. 2).
Auch die Rekonstruktionsgeschwindigkeit hat sich mit dem Aquilion PRISM nochmal verbessert. Da diese jedoch auch bei den alten CTs aus dem Hause Canon schon enorm schnell ist, also alle Bilder fertig rekonstruiert sind, sobald der Patient die Liege verlassen hat, merken wir diesen Unterschied kaum. Wir haben mit der Rekonstruktionsgeschwindigkeit noch nie ein Problem gehabt, sie ist im Workflow nie ein Nadelöhr gewesen.
Fazit: Der Einsatz der Deep Learning Rekonstruktionstechnologie AiCE liefert extrem klare, extrem deutliche Bilder. Schon die bisherige Bildgebung mit AIDR 3D der Canon CTs hatte sich schnell etabliert und galt im Team lange als die höchste technische Stufe. Nun zeigt die AiCE-Technologie: Es geht noch besser. Das führt zwangsläufig dazu, dass wir diese hohe Bildqualität gern all unseren Patienten zukommen lassen würden und nicht nur denen, die mit dem neuesten System untersucht werden. //
39-jähriger Pat., Z. n. venöser Stent-Anlage bei postthrombotischem Syndrom. Erbitte Gefäßdarstellung zur Stent-Revision.
Aquilion PRISM (AiCE)
DLP: 833,9 mGy*cm vs. 569,1 mGy*cm
Aquilion PRIME (AIDR 3D)
VISIONS 31 // 29 © 2021 C ANON MEDICAL SYSTEM S
Fall 1:




GIR
Aquilion PRISM (AiCE)
30 // VISIONS 31
Aquilion PRIME (AIDR 3D)
64-jährige Patientin, Troponinämie. V. a. KHK. Frage nach KHK. 55 kg, DLP 43,9 mGy*cm, CTDI vol. 3,7 mGy.







 RCA Rechter Hauptstamm
Linker Hauptstamm
Peripherer RIVA (AHA Seg. 8 + 10)
Fall 2:
RIVA
RCX
RCA Rechter Hauptstamm
Linker Hauptstamm
Peripherer RIVA (AHA Seg. 8 + 10)
Fall 2:
RIVA
RCX
VISIONS 31 // 31 © 2021 C ANON MEDICAL SYSTEM S
GIR
Fall 3:
76-jähriger Patient: geplante Rekanalisation bei CTO (chronic total occlusion) der RCA. Planungs-CT. CTDI vol.


3,1 mGy; DLP 37,3 mGy*cm, 80 kV, 76 – 81 BpM (763 ms), 1 Halbscan, 3 5– 5 5 %.



32 // VISIONS 31



RCA
VISIONS 31 // 33 © 2021 C ANON MEDICAL SYSTEM S
RIVA (wird zur Rekanalisation eingesetzt)
Gehirnblutung oder Gefäßverschluss
Handelt es sich um eine intrakranielle Blutung oder ist ein großes Gefäß verschlossen?
Ein Schlaganfall kann auf unterschiedliche Ursachen zurückzuführen sein. Deshalb ist es besonders wichtig, in kürzester Zeit über eine aussagekräftige Diagnostik zu verfügen.
Mit der Deep-Learning-basierten Auto-Stroke-Solution bringt Canon eine Lösung auf den Markt, die nicht nur selbstständig Bilder erstellt, sondern auch noch den Befundbericht dazu liefert.
Mit der Auto-Stroke-Solution präsentiert Canon eine Lösung, die in der Lage ist, ohne einen einzigen Klick unterschiedliche Arten von Schlaganfällen zu bestimmen und automatisiert eine detaillierte Auswertung zu erstellen. Um den Zustand des Schlaganfalls vollständig zu charakterisieren, analysiert das System, das auf Canons ebenfalls neuer Automation-Platform läuft, selbstständig CT-Scans. Den Notfallund Stroke-Teams werden in kürzester
Zeit Informationen zur Verfügung gestellt, die bei der klinischen Bewertung und Behandlung von Schlaganfällen helfen. „Die Auto-Stroke-Lösung integriert drei Schlaganfall-Applikationen, um sicherzustellen, dass die Untersuchung eine exakte Abbildung dessen liefert, was im Patienten vor sich geht“, beschreibt Michael Glasa, Produktmanager Healthcare IT und Manager Sales Support CT bei Canon Medical Systems, das neue System.

Diagnostik ohne Klick
Wenn die Zeit drängt, helfen die AutoStroke-Deep-Learning-Algorithmen bei Hirninfarktpatienten schnell, unterschiedliche Variationen einer intrakraniellen Blutung oder große Gefäßverschlüsse zu lokalisieren beziehungsweise die Penumbra und den potenziellen Infarktkern anzuzeigen. Denn die Kliniker benötigen schnellstmöglich Informationen, um in kurzer
TECHNOLOGIE // COMPUTED TOMOGRAPHY // Automation Platform
34 // VISIONS 31
Zeit fundierte Behandlungsentscheidungen treffen zu können. „Mit AutoStroke fassen wir nicht nur das Untersuchungsergebnis in einem Bericht zusammen, sondern stellen auch noch sicher, dass die Informationen ebenfalls auf mobilen Geräten, PCs oder im PACS eingesehen werden können“, erklärt Michael Glasa die Funktionsweise der Lösung für Schlaganfall-Netzwerke. Welche Therapie bei einem Schlaganfall die beste Option darstellt, hängt von vielen Faktoren ab. Speziell bei Verschlüssen großer Gefäße (LVO –Large Vessel Obstruction) scheint eine endovaskuläre Intervention im Vergleich zur systemischen Lyse bessere Ergebnisse zu liefern. Da im Falle einer Verlegung der Patient*innen eventuell Transportzeiten berücksichtigt werden müssen, ist eine möglichst exakte Diagnostik noch vor Ort von besonderem
Vorteil. Für die systemische Lyse gilt ein Zeitfenster von drei bis viereinhalb Stunden und für die endovaskuläre Intervention bis zu sechs Stunden – in Ausnahmesituationen bis zu 16 Stunden. Je früher nach dem Symptombeginn eine Reperfusion erreicht wird, desto erfolgversprechender sind bei beiden Therapiearten die Aussichten auf eine Besserung der Symptomatik.
Michael Glasa: „Eine schnelle Triage ist für den Patienten ausschlaggebend. Mit Auto-Stroke beschleunigen wir den gesamten Befundprozess. In weniger als 60 Sekunden analysieren die Algorithmen parallel die Bilder von bis zu drei unterschiedlichen Untersuchungen und die Befundberichte werden vollkommen automatisiert angefertigt, ohne dass eine Maus oder eine Tastatur bedient werden müssen.“

Automatischer Befundversand
Während die Scans der CT-Untersuchung bisher erst ins PACS übertragen und anschließend auf die Befundstation geladen werden mussten, um sie manuell zu bearbeiten, zu analysieren und einen Befundbericht zu diktieren, kommt Auto-Stroke ohne einen einzigen Mausklick aus. Denn die Automation-Platform von Canon automatisiert den gesamten Prozess, von der Bildanalyse bis zum fertigen Befund. Das heißt, die Bilder gelangen direkt vom Computertomographen zur Weiterverarbeitung, so dass der Radiologe beziehungsweise die weiterbehandelnden Ärzt*innen den Befund nur noch validieren müssen. Michael Glasa zu den Vorteilen der Auto-Stroke-Lösung von Canon: „Unsere Algorithmen kategorisieren die Bilder und analysieren dabei
Auto-Stroke beinhaltet das komplette Portfolio für die Schlaganfalldiagnostik.
„Die Auto-Stroke-Lösung integriert drei Schlaganfall-Applikationen, um sicherzustellen, dass die Untersuchung eine exakte Abbildung dessen liefert, was im Patienten vor sich geht“
© 2021 C ANON MEDICAL SYSTEM S
Michael Glasa, Produktmanager Healthcare IT und Manager Sales Support CT
bei
Canon Medical Systems.
AutoSTROKE-SOLUTION VISIONS 31 // 35
jedes einzelne Pixel. Die Software stellt sogar selbstständig fest, ob die Untersuchung mit oder ohne Kontrastmittel durchgeführt wurde.“ Handelt es sich um eine Untersuchung ohne Kontrastmittel, sucht Auto-Stroke nach einer Gehirnblutung und erkennt selbstständig die unterschiedlichen Arten: subdural, epidural oder subarachnoidal. Wurde bei der Untersuchung Kontrastmittel verwendet, sucht die Maschine nach einem Gefäßverschluss. Und auch Perfusionsstudien werden automatisiert ausgewertet. Sowohl die ausgewerteten Bilder als auch die maschinell erstellten Reports werden direkt ins PACS geschickt. Man kann das System auch so einstellen, dass es den Report per E-Mail entweder an die behandelnden Ärzt*innen oder zusätzlich an die Radiolog*innen versendet. Im PDF-
Befundbericht sind in den Bildern die verdächtigen Areale markiert beziehungsweise farblich hervorgehoben, so dass leicht zu erkennen ist, wo eine Veränderung stattgefunden hat.
Hohe Sensitivität und Spezifität
Trotz der enormen Verlässlichkeit des Algorithmus liegt es an den weiterbehandelnden Ärzt*innen, das automatisiert erstellte Ergebnis zu validieren. Für die Analyse intrakranieller Blutungen wurde der Deep-LearningAlgorithmus anhand von mehr als 10.000 Fällen trainiert. Die gemessene Sensitivität beträgt 92 Prozent und die Spezifität erreicht einen Wert von 97,5 Prozent. Bei der Unterscheidung von Gefäßverschlüssen liegen die Werte von Sensitivität und Spezifität

bei jeweils 98 Prozent. Bei der CT-Perfusionsmessung nutzt die Anwendung die Bayesischen CTP+-Algorithmen, um die Penumbra und den Infarktkern ohne einen einzigen Klick zu quantifizieren. Dabei können nicht nur 2D-, sondern auch 4D-Studien gleichermaßen ausgewertet werden. Der große Vorteil von Auto-Stroke besteht darin, dass die Kliniker*innen innerhalb kürzester Zeit einen kompletten Befundbericht zugeschickt bekommen, um schnell die richtige Therapie-Entscheidung treffen zu können. Das System ist in der Lage, innerhalb eines Zeitraums von etwa 30 bis maximal 60 Sekunden automatisiert und mit hoher Zuverlässigkeit Schädel-CT-Scans auszuwerten und unterschiedliche Arten von Schlaganfällen zu differenzieren. //



Automatisierte Befundberichte
▪ Für intrakranielle Blutungen
▪ Unterstützt die Erkennung mehrerer Varianten von Blutungen
▪ Benachrichtigt den Benutzer über das Vorhandensein einer DICOMBildausgabe, die das Vorhandensein einer potenziellen Blutung hervorhebt, und zeigt verdächtige Schichten an
Große Gefäßverschlüsse
▪ Liefert DICOM-Bilder, die das Vorhandensein einer potenziellen LVO in der M1- und M2-Region hervorheben
▪ Weist den Anwender auf das vermutete Vorhandensein einer LVO hin und zeigt die potenzielle Position und die vermuteten Schichten an, in denen die LVO sichtbar gemacht werden kann
Automatisierte Befundberichte
▪ Automatische Ausgabe von fünf parametrischen Karten: Zeit bis zum Maximum (Tmax), mittlere Transitzeit (MTT), relativer zerebraler Blutfluss (rCBF), relatives zerebrales Blutvolumen (rCBV) und Zeit bis zum Maximum (TTP)
▪ Übersichtskarten kommunizieren die Ergebnisse einer CT-Perfusionsuntersuchung und liefern eine Gewebeklassifizierung
36 // VISIONS 31
Olea Puls –mit „0“ Klicks in

30 Sekunden zum Report
Canon Medical Systems perfektioniert mit Olea Puls den Workflow in der Neuroradiologie. Die Anwender müssen keinen einzigen Klick tätigen, damit sie einen vollständigen Report bekommen, der essentiell für die weitere Behandlung sein kann.
„Time is Brain.“ Sobald für einen Patienten ein akuter Verdacht auf einen Schlaganfall im Raum steht, läuft bekanntlich die Stoppuhr. Die neurologische Abklärung und eine Hirnperfusionsuntersuchung zur weiteren Diagnostik im CT oder MRT sind binnen weniger Minuten abgeschlossen.




Aufgrund unterschiedlicher Expertisen beim Personal kann die anschließende Nachverarbeitung und Auswertung des Bildmaterials, normalerweise, ebenfalls einige Minuten dauern.
Canon Medical Systems bietet daher die Software Olea Puls an, die vollautomatisch und selbstständig CToder MRT-Perfusionsbilder des Kopfes auswertet, einen Report erstellt und diesen ins PACS einstellt und/oder per E-Mail an den behandelnden Arzt verschickt. Die Erstellung des vollständigen Reports dauert in der Regel ca. 30 Sekunden. Ein sehr wertvoller Zeitgewinn, der dem Patienten zugutekommt.
Der Report enthält bei einer CT-Hirnperfusion Angaben zu rBF, rBV, MTT, TTP, TMAX, tMIP.
Bei einer MRT-Hirnperfusion enthält der Report Angaben zu B1000, ADC, rBF, rBV, MTT, TTP, TMAX.
Unterschiedliche Color-Maps mit eindeutigen Infarktzeichen der linken Hirnhälfte.
https://de.medical.canon
Eindeutige Visualisierung des Infarktkerns (rot) sowie der Penumbra (gelb). Zusätzlich werden die Volumina, das Mismatch Ratio und das Relative Mismatch dargestellt.
rBV MTT rBF TMAX tMIP TTP

38 // VISIONS 31
Advanced intelligent Clear-IQ Engine AiCE für MR
Eine praktische Deep-Learning-Reconstruction-Anwendung für den Einsatz im MRT.
Canon Medical hat für seine MRTs der Serien Vantage Orian, Vantage Galan 3T und den Vantage Elan-NX Edition die Advanced intelligent Clear-ImageQuality Engine (AiCE) vorgestellt. Durch den Einsatz neuester Hochleistungsrechner in Kombination mit einem DCNN (Deep Convolutional Neural Network) wird das Rauschen in den MR-Bildern weitestgehend eliminiert. Dies stellt einen am Markt einzigartigen Ansatz in der Verbesserung der MRBildqualität dar. Die nachfolgenden aufgezeigten Zusammenhänge zwischen Signal und Rauschen bei MR-Bildern sollen zum besseren Verständnis beitragen.

Das Signal-Rausch-Verhältnis (SNR) in MR-Bildern
Das SNR stellt eine wichtige Kenngröße zur Beurteilung von MR-Bildern dar. Es ergibt sich aus dem Quotienten der Signalstärke S und der Stärke des Rauschens.
Das Signal hängt im Wesentlichen von folgenden 3 Faktoren ab:
1. Feldstärke des MR-Systems
2. Größe des untersuchten Pixels (bzw. Voxels)
3. Aufnahmedauer
Das Rauschen hat im Wesentlichen 3 natürliche Ursprungsorte:
1. den menschlichen Körper
2. die HF-Spule
3. den Signalweg bis zur Digitalisierung,
Zusätzlich können externe Störquellen zum Rauschen beitragen.
Das Rauschen hat man mit der Entwicklung optimierter Signalwege (optimierte Spulen, rauscharme Vorverstärker, frühe Digitalisierung …) und der Minimierung externer Störquellen (HF-Kabine, wirbelstromarme Komponenten, gekapselte Elektronik …) fast auf das Niveau des Körper-Rauschens reduziert.
© 2021 C ANON MEDICAL SYSTEM S
AiCE // MAGNETRESONANZTOMOGRAPHIE // VANTAGE ORIAN, GALAN 3T UND ELAN-NX EDITION
Signal Rauschen SNR = VISIONS 31 // 39
Das Signal kann durch die Auswahl des richtigen Systems (3T oder 1,5T) und durch bekannte „Einstellungen“ bei der Sequenzwahl erhöht werden.
Diese Einstellungen verbinden immer Vorteile in einem Aspekt mit Nachteilen an anderer Stelle. Beispielsweise verbessert sich mit der Vergrößerung des Bildelements (Voxels) das Signal, aber gleichzeitig verschlechtert sich auch die Auflösung. Eine Verlängerung der Aufnahme durch mehr Mittelungen führt zu einem verbesserten Signal, aber auch zu einer längeren Untersuchung und einer höheren Gefahr für Patientenbewegungen. Anspruchsvollere Einstellungen, wie eine Verkleinerung der Bandbreite zur Verbesserung des Signals, führt letztendlich auch zu einer zeitlichen Verlängerung der Aufnahme und hat auch andere „Nebenwirkungen“, wie eine Vergrößerung des Chemical-Shift-Effektes.
Wichtig ist, dass Signal und Rauschen in einem Gleichgewicht sind, wobei das Signal immer größer als das Rauschen sein muss.



Bevor wir uns jetzt in den Tiefen der Sequenzoptimierung verlieren, kommt hier das für den Anwender einfache Verfahren AiCE ins Spiel, das einfach das Rauschen aus dem Bild entfernt.
Wie AiCE das Rauschen erkennt Wir alle können das Rauschen vom Signal trennen. Erinnern wir uns: Wenn wir mit den Eltern oder Großeltern alte, schlecht aufgelöste Bilder im Album oder aus der Grabbelkiste angeschaut haben, haben die Eltern Tante Erna immer auf den schlechtesten Bildern erkannt, während wir nur staunen konnten. Und warum ? Weil sie das Charakteristische des Gesichts von Tante Erna kannten und noch unter der dicksten Patina erkennen können, weil sie es gelernt haben, dieses Gesicht
zu erkennen. Ihr Gehirn ist darauf trainiert. Unser Gehirn konnte dagegen auch jemand erkennen, aber nicht die exakte Person.
Und so ähnlich ist es mit AiCE. In der Trainingsphase erhält ein DeepConvolutional-Neural-Network gute Bilder (z. B. Bilder mit hohem SNR, die mit 10 Mittelungen aufgenommen wurden) und das entsprechende verrauschte Bild (z. B. Bilder mit nur einer Mittelung oder künstlich verrauschte Bilder).





















Nach dieser Trainingsphase mit tausenden von Bildern erkennt das DCNNetzwerk das Rauschen. Nach der Trainingsphase wird das DCN-Netzwerk (AiCE-MR) probeweise implementiert und klinisch getestet. Dies erfolgte unter anderem in Zusammenarbeit mit Prof. Vincent Dousset (CA Neuroradiologie des Klinikums der Universität Bordeaux) und Prof. Thomas
Tourdias (Radiologe am Klinikum der Universität Bordeaux).
Nach Abschluss der Evaluierungsphase kann AiCE-MR auf einem entsprechend ausgelegten Hochleistungsrechner (in Kooperation mit NVIDIA entwickelt) implementiert werden und in der Routine angewendet werden.
Niedriges SNR
und Rauschen zu unterscheiden. Deep Learning
Anwendungsphase Nach Abschluss der Trainingsphase kann AiCE auf intelligente Art das Rauschen reduzieren und das SNR erhöhen.
Hohes SNR
Datenaufnahme AiCE
Abb. 1: Das Deep-Learning-Netzwerk lernt mit tausenden von Bildern das Rauschen vom Signal zu unterscheiden.
Abb. 2: In der Anwendungsphase ist AiCE-MR in die normale MR-Oberfläche integriert und verrichtet dort ohne weitere Interaktion seine Arbeit.
40 // VISIONS 31
(1) Daten aufnehmen und Bild rekonstruieren
(2) Abschätzung des Rauschens aus Daten und speziellem Prescan (Map) Automatische Rauschinfo
(6) Hochfrequente und niederfrequente Daten wieder vereinigen
(5 a) Hochfrequente Daten werden „entrauscht“


(5 b) Niederfrequente Daten (Kontraste) bleiben
AiCE, der Filter, der mehr als ein Filter ist Obwohl AiCE wie ein gewöhnlicher Filter auf der Oberfläche des MRTs aktiviert werden kann und auch ähnlich wie ein herkömmlicher Filter dem Geschmack des Betrachters angepasst werden kann, steckt sehr viel mehr dahinter.
Schon vor und während der Aufnahme des MR-Bildes (1) erkennt das MR das Rauschniveau (2). Dieses wird später während der DLR-Prozedur benötigt. Das Rauschniveau wird aus 2 Quellen berechnet: Die eine Quelle ist das Bild selbst, die zweite Quelle ist in den sogenannten MAP-Scan integriert.

(7) Das Originalbild wird in das DLR-Bild eingeblendet für einen natürlichen Bildeindruck
5 a ist die zentrale AiCE-Prozedur
(8) Das finale Bild wird mit dem gewählten Einblendniveau erzeugt

Das Einblendniveau ist anpassbar Kantenanhebung anwählbar
(9) Schärfung des Bildes mit einem klassischen Kantenanhebungsfilter auf Wunsch
Der MAP-Scan dient der Intensitätskorrektur bei allen Mehrkanalspulen.
Während der DLR-Prozedur (3–6) werden die MR-Bilddaten in ihre hochund niederfrequenten Anteile zerlegt. Die niederfrequenten Anteile (5 b) werden nicht bearbeitet, da sie die Kontraste bestimmen und damit für die Diagnostik unverändert bleiben sollen. Die hochfrequenten Anteile werden mit der eigentlichen DLRProzedur „entrauscht“ (5 a). Das Entfernen des Rauschens ist dabei adaptiert an das Rauschen des MRTs und seiner Komponenten, das im Rahmen des MAP-Scans ermittelt wurde, und an das individuelle Rauschen des einzel-


Die automatische Rauschinfo und die Aufspaltung in hochfrequente und niederfrequente Anteile
(4) benötigen direkte Info vom Scanner bzw. K-Raum-Daten Hier können Einstellungen angepasst werden
nen Bildes. Der automatisch ermittelte Rausch-Grenzwert kann dem eigenen Geschmack mittels „AiCE Adjust“ angepasst werden.
Danach werden die hochfrequenten und niederfrequenten Anteile des Bildes wieder zusammengeführt (6). Da dies Bild zu glatt und damit unnatürlich erscheint, wird das ursprüngliche Bild wieder eingeblendet (7 + 8). Das Einblendniveau kann dabei individuell variiert werden (siehe Abb. 4).
Vor der finalen Ausgabe kann das Bild noch mit einem klassischen Kantenanhebungsfilter geschärft werden.
unberührt
(4) Aufspaltung in hochfrequente und niederfrequente Anteile
Das Rauschniveau ist anpassbar
Nativ d01 (70 % Nativ) (30 % Entrauscht) (30 % Nativ) (70 % Entrauscht) Entrauscht d02 d03 d04 d05
(3) Start DLR-Prozedur
Abb. 3: Die wichtigsten Schritte von der Aufnahme bis zur Erstellung eines mit AiCE optimierten Bildes.
VISIONS 31 // 41 © 2021 C ANON MEDICAL SYSTEM S
Abb. 4: Prinzip des Einblendens des nativen Bildes in das „entrauschte“ Bild. Dabei sind das native und das entrauschte Bild in der hier gezeigten Form nicht sichtbar.
Klinische Vorteile von AiCE in der Routine Da AiCE das Rauschen vermindert, haben wir bei der Aufnahme die Möglichkeit, das Signal des MR-Bildes zu verkleinern, ohne das Gleichgewicht von Signal zu Rauschen ungünstig zu beeinflussen. Dieser Effekt kann entweder dazu genutzt werden, um Bilder schneller aufzunehmen und somit die Untersuchungszeit zu verkürzen oder um Bilder mit kleineren Voxeln aufzunehmen und somit die Auflösung zu verbessern. Beide Effekte können erreicht werden, weil durch AiCE das Signal-Rausch-Verhältnis verbessert wird.
Ziel der Forschungen an der Universität Bordeaux war die hochaufgelöste und detailreiche Darstellung spezieller Hirnareale, wie des Hippocampus oder des Claustrum. Diese Regionen hatte Prof. Tourdias schon am 7T-System bei seinem Aufenthalt an der Stanford-Universität studiert. Nun war es mit der AiCE-Technologie möglich, vergleichbar aufgelöste Bilder auch bei 3T in akzeptabler Untersuchungszeit zu erzeugen (siehe Abb. 5 a und b).



Natürlich lassen sich die Vorteile einer höheren Auflösung nicht nur in der klinischen Forschung nutzen, sondern sind auch dazu geeignet, bei-
 Abb. 5 a + b: Hochaufgelöstes Bild des Hippocampus; 0,15 mm x 0,15 mm; 2 mm Schichtdicke; rechts mit AiCE-Rekonstruktion. Mit freundlicher Genehmigung des Unversitätsklinikums Bordeaux.
Abb. 6 a + b: Hochaufgelöstes Bild des Knies; 0,15 mm x 0,15 mm (interpoliert); 1 mm Schichtdicke; rechts mit AiCE-Rekonstruktion.
Abb. 5 a + b: Hochaufgelöstes Bild des Hippocampus; 0,15 mm x 0,15 mm; 2 mm Schichtdicke; rechts mit AiCE-Rekonstruktion. Mit freundlicher Genehmigung des Unversitätsklinikums Bordeaux.
Abb. 6 a + b: Hochaufgelöstes Bild des Knies; 0,15 mm x 0,15 mm (interpoliert); 1 mm Schichtdicke; rechts mit AiCE-Rekonstruktion.
42 // VISIONS 31
spielsweise einen Knorpelschaden im Knie im Detail zu zeigen.
Durch die alternative Nutzung des SNR-Gewinns durch AiCE werden MR-Untersuchungen ohne Auflösungsverlust beschleunigt. Der große klinischen Vorteil bei diesem Einsatz von AiCE ist, dass es bei Patienten zu weniger Artefakten durch Bewegung kommt. Die Quote von Wiederholungsaufnahmen wird deutlich reduziert bei gleichzeitiger Steigerung des Bildqualität. Vereinfacht gesagt steigt die Untersuchungskapazität des MRTs. Zur Beschleunigung der Untersuchungsdauer eignet sich besonders das neue Compressed-SPEEDER-Verfahren, das völlig unabhängig von Spulentyp und Untersuchungsrichtung zum Einsatz kommt.
A T1-Gewichtung; Auflösung 0,35 mm x 0,35 mm; 59 Sek.


B T2-Gewichtung; Auflösung 0,3 mm x 0,3mm; 57 Sek.
Integration in die M-Power-6-Oberfläche

Obwohl die Deep-Learning-RekonstruktionAnwendung AiCE auf einem separaten Hochleistungsrechner durchgeführt wird, ist die Prozedur nahtlos in den Routineablauf eingebaut. Der Patient wird gescannt, die Bilder werden rekonstruiert und auf Wunsch auch automatisch ins PACS gesendet. Fertig, aus.
Selbstverständlich kann man seine individuellen Einstellungen vornehmen. Dies geschieht vor-
nehmlich in der Einarbeitungsphase. Dort können drei Parameter den individuellen Wünschen angepasst werden. Dies sind eine Anpassung des automatisch gemessenen Rauschniveaus um einen Faktor von 0,7 bis 2,0, die Stärke der Einblendung von 30 bis 70 % des Originalbildes und eine mögliche Kantenanhebung (ON oder OFF).
Natürlich kann man auch verschiedene Einstellungen erproben, ohne die Untersuchung wiederholen zu müssen.
Abb. 7 a + b: LWS-Aufnahmen mit Compressed SPEEDER zur Beschleunigung und AiCE zur Rauschentfernung;
Abb. 8: Menü zur Aktivierung von AiCE im InLine-Postprocessing-Menü: A Aktivierung von AiCE oder einem anderen Filter; B + B1 Einstellung des Einblendungsfaktors d01–d05; C + C1 Anpassung des Rauschniveaus; D Aktivierung des Kantenanhebungsfilters.
VISIONS 31 // 43 © 2021 C ANON MEDICAL SYSTEM S
Sicherheit von AiCE
AiCE fügt den MR-Bildern keine zusätzlichen Informationen hinzu und somit können prinzipbedingt keine falsch positiven Befunde erzeugt werden. Kleine, diskrete Strukturen könnten versehentlich entfernt werden, wenn das Rauschniveau die gleiche Signalstärke wie die kleinen, diskreten Strukturen erreicht und diese Strukturen sich über sehr wenige Pixel erstrecken. Deswegen ist es wichtig, das Rauschniveau („AiCE Adjust“) nur mit größter Sorgfalt zu verändern. Im Gegensatz zu systemunabhängigen Algorithmen bestimmt AiCE das Rauschniveau vollautomatisch aus 2 Informationsquellen des MRTs, wodurch die Sicherheit erhöht wird. Im Rahmen der Evaluierung von AiCE wurden Bilddaten aus verschiedenen unabhängigen Instituten international erzeugt. Diese Bilddaten wurden von 6 verschiedenen zertifizierten Radiologen bewertet. Die damit durchgeführte Studie wurde von der amerikanischen FDA für die Zulassung von AiCE anerkannt und ist auch die Grundlage der CE-Zertifizierung.
AiCE-Zusammenfassung
Das AiCE-Rekonstruktionsverfahren ist technisch aufwendig, im Hintergrund aber einfach in der Routine einsetzbar. Es ist durch die intelligente Entfernung von Rauschen aus den MR-Bildern entweder indirekt zur Beschleunigung von Aufnahmen zu verwenden oder ermöglicht rauscharme, hochaufgelöste Bilder. AiCE ist prinzipbedingt sicher. Es ist grundsätzlich an keinen Sequenztyp gebunden, funktioniert aber besonders gut bei hohen Auflösungen. //

44 // VISIONS 31
Produktivität, Patientenkomfort und klinische Sicherheit auf neuem Niveau
Vantage Orian steht für gesteigerte Produktivität und niedrigere Betriebskosten, für sicheren Patientenkomfort und kompromisslose klinische Verlässlichkeit. Der Vantage Orian 1.5T ist die perfekte Lösung für alle Ihre betrieblichen und klinischen Anforderungen.

https://de.medical.canon

// VISIONS 31
Das klinikum Fürth ist Akademisches Lehrkrankenhaus der Friedrich-Alexander-Universität Erlangen-Nürnberg
Roboterbasiertes Röntgen im Klinikum Fürth
Die Radiologie im Klinikum Fürth arbeitet seit Mitte 2020 mit zwei volldigitalen Adora DRi Systemen und drei mobilen X-Ray Units von Canon Medical Systems. Im Interview sprechen PD Dr. Thomas Bayer, Chefarzt Allgemeinradiologie, Prof. Dr. Stephan Kloska, Chefarzt Neuroradiologie, und die leitenden MTRA, Stefanie Mattner, über die Vorteile der neuen Systeme und darüber, inwiefern sie gerade auch zu Corona-Zeiten davon profitieren.
Was zeichnet Ihr Haus und speziell die Radiologie aus? Welche Besonderheiten gibt es?

Dr. Thomas Bayer: Unser Haus verfügt über 800 Betten und diese Zahl wächst weiter. Unsere Röntgenabteilung wird für das gesamte Spektrum genutzt, akut, elektiv, ambulant und stationär. Das Klinikum Fürth hat eine große Notaufnahme, die direkt an die Röntgenabteilung angrenzt. Insofern ist unser konventionelles Röntgen insbesondere auch nachts und am Wochenende im Notfallbetrieb im Dauereinsatz. Hierbei decken wir das gesamte Spektrum der Akutversorgung ab, sowohl bei neuroradiologischen als auch bei allgemeinradiologischen Indikationen.
Welche speziellen Anforderungen werden dadurch an Ihre Abteilung und Ihre Röntgensysteme gestellt?
Prof. Dr. Stephan Kloska: Durch unsere sehr aktive Notaufnahme haben wir einen großen Anteil an Patienten mit eingeschränkter Mobilität und nachts ist manchmal nur eine MTRA im Einsatz. Darum brauchen wir ein System, bei dem die Patienten einfach und auch von einer Person alleine umgelagert werden können. Da kommt uns die Funktionalität des Adora Systems, bei dem keine Umlagerung in der 2. Ebene erforderlich ist, sehr entgegen. In der ersten Pandemiewelle wurden rund 50 Prozent der COVID19Fälle der Region im Klinikum Fürth behandelt, in Hochzeiten waren es bis zu 90 stationäre Patienten. Gerade in
INTERVIEW // X-RAY // Adora DRi
VISIONS 31 // 47 © 2021 C ANON MEDICAL SYSTEM S
dieser Phase, wo der Andrang mit Patienten auf COVIDVerdacht ausgesprochen groß war und ist und wir schnell nach COVIDPatienten und Verdachtsfällen vorsortieren mussten, konnten wir mit dem Adora System in der Notaufnahme sehr schnell agieren.
Sie haben Ihre Abteilung im Bereich konventionelle Röntgendiagnostik komplett neu aufgestellt. Gab es einen konkreten Anlass für den Umstieg auf das volldigitale System?
Dr. Thomas Bayer: Ein Komplettwechsel zu einem volldigitalen System war die einzig denkbare Option für uns. Am roboterbasierten Röntgen
kommt man heute einfach nicht mehr vorbei.
Prof. Dr. Stephan Kloska: Grundsätzlich kann man sagen, dass es die Überlegungen, auf ein volldigitales System umzusteigen, schon länger gab. Aber die CoronaPandemie hat die Anschaffung noch einmal maßgeblich beschleunigt.
Ihre Bucky-Räume wurden durch zwei Adora DRi Systeme ersetzt. Sind Sie zufrieden mit dem neuen System? Was sind besondere Vorteile?
Dr. Thomas Bayer: Mit dem Adora System können wir die Aufnahmerichtung der Bildgebung jederzeit optimal einstellen, ohne den Patienten umlagern zu müssen, wie beispielsweise bei axialen Aufnahmen beider Hüftgelenke. Kraftsparende Arbeitsabläufe, eine durchdachte Menüführung und um

fassende AutoPositionierung unterstützen unsere MTRAs. Das System lässt sich fernsteuern, ohne dass man an den Patienten unmittelbar herantreten muss. Die Tatsache, dass das System von außen zu bedienen ist, ist natürlich gerade auch in der CoronaPandemie hinsichtlich der einzuhaltenden Isolationsmaßnahmen und Hygienevorschriften ein wichtiges Argument.
Prof. Dr. Stephan Kloska: ... und wir können deutlich wirtschaftlicher arbeiten als mit dem alten Speicherfoliensystem, das vorher im Einsatz war.
Auch das mobile Röntgen auf den Stationen wurde umgestellt. Wie sind dort Ihre Erfahrungen?
Prof. Dr. Stephan Kloska: Die mobilen Geräte haben Handling und Workflow deutlich verbessert. Das alte System

„Da kommt uns die Funktionalität des Adora Systems, bei dem keine Umlagerung in der 2. Ebene erforderlich ist, sehr entgegen.”
„Am roboterbasierten Röntgen kommt man heute einfach nicht mehr vorbei.”
Dr. Thomas Bayer Chefarzt Allgemeinradiologie
48 // VISIONS 31
Prof. Dr. Stephan Kloska Chefarzt Neuroradiologie
59-jähriger männlicher Patient mit Z.n. periprothetischer Fraktur nach Hüft-TEP; Abb. links: Oberschenkelaufnahme in Stitching-Technik zur präoperativen Planung, Abb. rechts: Post-OP-Dokumentation.


stieß an seine Grenzen. Gerade in den COVIDBereichen sind wir viel mobil unterwegs, weil sich die Mitarbeiter so nur einmal umziehen müssen. Beim alten System haben wir eine Kassette pro Patient benötigt, die ausgelesen werden musste. Jetzt sparen wir uns den umständlichen Kassettenwechsel und über die wireless verfügbaren Worklists können die Daten außerdem direkt den einzelnen Patienten zugeordnet werden.
Dr. Thomas Bayer: Mit den motorbetriebenen Einheiten sind wir schnell im Haus unterwegs. Und das System passt mühelos in den Fahrstuhl, das ist ein wichtiges Argument. So können wir zügig die einzelnen Aufträge aus den Stationen erfassen und abarbeiten. Damit das mobile Röntgen nicht inflationär genutzt wird, machen unsere MTRAs mittlerweile jeweils eine „RöntgenRunde“ für elektive COVIDRöntgenfälle am Vor und eine am Nachmittag.
Hat sich die Arbeitsbelastung für die Mitarbeiter dadurch verändert?
Stefanie Mattner: Für uns ist es grundsätzlich ein großer Vorteil, dass wir mit dem Adora System spontan zwischen Betten und mobilem Betrieb wechseln können. Bei der Arbeit mit den mobilen Geräten auf Station ist der logistische Aufwand deutlich geringer geworden. Jetzt müssen wir statt der Kassetten nur noch einen Detektor tragen, das macht das Handling für unser Team sehr viel einfacher. Außerdem funktioniert der Patientenwechsel schnell und vollautomatisch, das erleichtert uns die Umlagerung gerade auch bei adipösen Patienten enorm. Und auch für die Patienten selbst ist das natürlich viel komfortabler.
Wie zufrieden sind Sie mit der Bildqualität und der reduzierten Strahlenbelastung?
Dr. Thomas Bayer: Bei einem roboterbasierten System ist eine perfekte
Ausrichtung der Strahlenquelle zum Detektor möglich. Dadurch ist es deutlich einfacher, eine optimale Bildqualität bei hoher Dosisreduktion zu erzielen.
Prof. Dr. Stephan Kloska: … was natürlich von den Einstellungen abhängt, da mussten wir noch etwas nachjustieren. Wir haben die Positionierung verändert und die Messkammern umgestellt und die MTRAs mussten eine etwas andere Vorgehensweise wählen. Die Parameter der Canon Bildverarbeitung wurden letztlich so eingestellt, dass Bildeindruck und Dosisreduktion unseren hohen Anforderungen entsprechen.
Sie arbeiten mit speziellen Flachdetektoren. Was sind dabei die besonderen Eigenschaften?
Dr. Thomas Bayer: Die Flachdetektoren sind leicht zu bedienen und funktionieren selbsterklärend.
VISIONS 31 // 49 © 2021 C ANON MEDICAL SYSTEM S
Prof. Dr. Stephan Kloska: Von unseren MTRAs haben wir außerdem die Rückmeldung bekommen, dass die Flachdetektoren nur unwesentlich schwerer sind als die bisherigen Röntgenkassetten. Das ist fürs tägliche Handling natürlich entscheidend.
Stefanie Mattner: … und durch die eingelassenen Griffmulden auf der Rückseite sind sie besser zu transportieren. Die Gefahr des Fallenlassens ist deutlich geringer. Auch die Reinigung der Flachdetektoren gestaltet sich aufgrund ihrer hohen Wasserbeständigkeit unkompliziert. Nicht zu vergessen das DetektorSharing: Wir haben im Haus insgesamt sechs Canon Flachdetektoren in zwei unterschiedlichen Größen im Einsatz, die wechselseitig mit allen Canon Systemen betrieben werden können, wodurch wir flexibler sind und die Ausfallsicherheit erhöht wird.
Wie hat die Einführung des neuen Systems unter den erschwerten Corona-Bedingungen funktioniert?
Dr. Thomas Bayer: Das hat trotz der Ausnahmesituation erfolgreich geklappt. Canon hat sich vorbildlich verhalten. //
Vielen Dank für das Gespräch.
Klinikum Fürth
• Das Klinikum Fürth ist Akademisches Lehrkrankenhaus der FriedrichAlexanderUniversität ErlangenNürnberg und hat 2.500 Mitarbeiter.
• Jährlich werden zirka 58.000 ambulante und zirka 42.000 stationäre Patienten versorgt.
• Radiologie und Neuroradiologie: Schwerpunkte des Instituts sind die interventionelle Radiologie und die Neuroradiologie. Es werden alle gängigen radiologischen und neuroradiologischen minimalinvasiven Behandlungen durchgeführt.



• PD Dr. med. Thomas Bayer (Chefarzt Allgemeinradiologie)
• Prof. Dr. med. Stephan Kloska (Chefarzt Neuroradiologie)
Stefanie Mattner Leitende MTRA
50 // VISIONS 31
65-jähriger männlicher Patient; Abb. links: Notaufnahme Röntgen Liegendthorax bei Verdacht auf COVID-19-Pneumonie, Abb. rechts: CT-Bestätigung der COVID-19-Pneumonie am gleichen Tag.
Zweiebenen-Angiographiesystem mit Multi-Achsen-Bodenstativ

• vollständige Patientenabdeckung ohne Tischbewegung
• Advanced Image Processing für 2D- und 3D-Bildgebung
• High-Definition Flachdetektortechnologie
• DoseRite Dosisreduktions-Paket
• hohe Ausfallsicherheit des Gesamtsystems
Weitere Informationen finden Sie auch unter: https://de.medical.canon
https://de.medical.canon
Neuartige High-DefinitionTechnologie: „Wie ein Mikroskop für den Neuroradiologen“

Die Alphenix Angiographiesysteme von Canon Medical können nun mit innovativer HD-Technologie ausgestattet werden. Mit dem weltweit ersten hochauflösenden Flachdetektor für die Angiographie sind kleinste Gefäße und Gefäßanomalien mit kleinsten interventionellen Devices besser behandelbar. Im Interview spricht Matthias Schmidbauer, Manager Sales Support X-Ray bei Canon Medical Systems, über die Vorteile der neuartigen HD-Technologie für neurovaskuläre Eingriffe.

INTERVIEW // X-RAY // HD-TECHNOLOGIE
52 // VISIONS 31
Was zeichnet die Alphenix Angiographiesysteme mit der neuen HD-Technologie von Canon Medical Systems aus?
Diese neuartige Technologie ist das Ergebnis jahrelanger Forschungsarbeit, die wir in Zusammenarbeit mit führenden Kliniken, wie dem Gates Vascular Institute in Buffalo, geleistet haben. Es ist uns gelungen, den weltweit ersten hochauflösenden Flachdetektor für die dynamische Bildgebung in der Angiographie zur Marktreife zu führen. Die Auflösung des HD-Flachdetektors konnten wir auf außergewöhnliche
6,5 Linienpaare pro Millimeter steigern –

auf einen ca. doppelt so hohen Wert, verglichen mit konventionellen Systemen. Um jetzt auf Ihre Frage zurückzukommen, können damit kleinste Gefäße und Gefäßanomalien mit
kleinsten interventionellen Devices sicherer und schneller behandelt werden, was diese Technologie insbesondere für die Behandlung zerebraler Gefäßerkrankungen prädestiniert.
Standard-Flachdetektor
Was macht die neue HD-Technologie so besonders?
Wenn Neuroradiologen beispielsweise intrakranielle Aneurysmen mit dem endovaskulären Coiling-Verfahren behandeln, benötigen sie Sichtkontakt zur Läsion. Je besser sie die feinen, über einen Mikrokatheter in das Aneurysma vorgeschobenen Platinspiralen, die sogenannten Coils, sehen, desto präziser
HD-Flachdetektor
und zügiger können sie diese im Aneurysma packen und dessen Innenwand abdecken. Häufig muss die entfaltete Platinspirale zusätzlich noch durch einen Stent mit sehr feinem Drahtgeflecht gestützt werden, der ebenfalls genau zu platzieren ist.



Durch die Vergrößerungsmöglichkeit im HD-Modus können diese kleinen
Devices und Gefäßstrukturen auf dem Monitor klar dargestellt werden. Somit ist auch der Behandlungsfortschritt genauer nachvollziehbar. Der HDFlachdetektor funktioniert in diesem Zusammenhang wie ein Mikroskop für den Neuroradiologen. Es leuchtet ein, dass die HD-Technologie daher zu besseren Behandlungsergebnissen und höheren Überlebensraten führt.
Klinischer Fall: 11 mm Kavernöses Karotisaneurysma rechts; Behandlung mit LVIS-Blue-Stent und Coils; Bildgebung mit lateralem HD-Flachdetektor, 6 cm x 6 cm FOV, Fluoro-Modus.
VISIONS 31 // 53 © 2021 C ANON MEDICAL SYSTEM S
Bildgebung mit Standard- und HD-Flachdetektor.

Was können Sie zur Qualität des vergrößerten Bildes sagen?
Die Bildqualität ist herausragend. Die Pixeldichte unseres HD-Flachdetektors ist so hoch, dass ein Detektorsichtfeld (englisch: field of view) der Größe von 8 cm x 8 cm auf einem 19-Zoll-Monitor bildschirmfüllend in nativer Auflösung dargestellt wird. Ohne an Bildqualität zu verlieren, sind native Vergrößerungen bis zu einem Detektorsichtfeld von 4 cm x 4 cm möglich. Im Vergleich dazu können Standard-Angiographiesysteme nur bis zu einem Detektorsichtfeld von ca. 8 cm x 8 cm nativ vergrößern. Das auf dem oben genannten Monitor angezeigte native Bild hätte dann nur eine Größe von einem Viertel der Displayfläche. Für die bildschirmfüllende Darstellung müssten die angezeigten Detektorpixel auf die doppelte Größe „aufgebläht“ werden, was natürlich mit einem Verlust an Bildqualität einhergehen würde.
Eröffnen sich durch HD Imaging neue Behandlungsmöglichkeiten?
Der Trend geht zur Behandlung immer kleinerer Gefäße und Gefäßanomalien. Dafür werden immer kleinere Devices verwendet und eine dementsprechend höherwertige Bildgebung wird benötigt. Die HD-Technologie eröffnet daher grundsätzlich mehr Behandlungsmöglichkeiten, gerade bei neurovaskulären Eingriffen. Die Manipulation von Mikrokathetern im Gefäßbaum vereinfacht sich. Dabei ist nochmals zu betonen, dass der HD-Modus für die dynamische Bildgebung verfügbar ist. Der Kliniker kann also die Coils und feinen Stentstrukturen in HD und Echtzeit sehen. Insgesamt kann hochpräzise interveniert und der Einsatz von offener Chirurgie noch länger umgangen werden.
Ist das System trotzdem leicht zu bedienen?
Die Vergrößerung und Umschaltung in den HD-Modus funktioniert komplett intuitiv, der Anwender kann mühelos in die „Region of Interest“ hineinzoomen. Für ihn ist daher keinerlei Umstellung nötig. Er wird sich bei seinen minimalinvasiven Eingriffen noch sicherer fühlen als zuvor.
Die Faktoren zur höheren Vergrößerung bedeuten doch zugleich auch eine höhere Dosis für den Patienten? Das könnte man vermuten. Es ist jedoch einerseits so, dass die HD-Unterstützung variabel einsetzbar ist, also nur bei Bedarf zugeschaltet wird, während das System sonst im Normalmodus arbeitet. Andererseits kann mit HDUnterstützung die Dauer des gesamten Eingriffs signifikant verkürzt werden, weil der Kliniker eine bessere Sicht auf
INTERVIEW // X-RAY // HD-TECHNOLOGIE
„Die HD-Technologie eröffnet daher grundsätzlich mehr Behandlungsmöglichkeiten, gerade bei neurovaskulären Eingriffen.“
54 // VISIONS 31
Matthias Schmidbauer
Hautdosis bei neurovaskulären Interventionen: Peak-Hautdosis in mGy; Gegenüberstellung RAD-IR-Studie1 und GVI-Studie mit HD-Flachdetektor2
Dosisindikatoren bei neurovaskulären Interventionen: Eingriffszeit, Durchleuchtungszeit, Anzahl der Strahlungsereignisse und Luftkerma vor (Pre-HD, n = 1.702) und nach (Post-HD, n = 1.645) Einführung der HD-Flachdetektortechnologie3
das Geschehen hat. Aufgrund der geringeren Durchleuchtungszeiten und der geringen Anzahl von Strahlungsereignissen kann die Gesamtdosis daher sogar verringert werden. Erste Studien vom Gates Vascular Institute haben für neurovaskuläre Interventionen gezeigt, dass bei Nutzung der HDTechnologie die Behandlungsfälle mit einer Patientenhautdosis über 1 Gray von 78 auf 12 Prozent und die Eingriffszeiten um 11 Prozent reduziert werden konnten. Nicht zu vergessen, dass die HD-Technologie gemeinsam mit der DoseRite Dosisreduktionstechnologie eingesetzt wird.
Für wen ist die neuartige HDTechnologie besonders sinnvoll?
Für neuroradiologische Kliniken im universitären Umfeld oder Krankenhäuser mit dedizierter Neuroradiologie. Auch für Spezialzentren, in denen hochkomplexe neurovaskuläre Interventionen durchgeführt werden, ist der Einsatz der HD-Technologie besonders empfehlenswert. //
Vielen Dank für das Gespräch.
Quellen
1. D. L. Miller et al., The RAD-IR Study Part II –Skin Dose, Journal of Vascular and Interventional Radiology: JVIR, 01 Aug 2003, 14(8):977–990, Radiation Doses in Interventional Radiology Procedures.


2. Mit freundlicher Genehmigung von Dr. A. H. Siddiqui, Gates Vascular Institute Buffalo, NY.
3. Mit freundlicher Genehmigung von Dr. A. H. Siddiqui, Gates Vascular Institute Buffalo, NY.
VISIONS 31 // 55 © 2021 C ANON MEDICAL SYSTEM S
Professor Karsten Knobloch, FACS, ist Facharzt für Allgemeine, Plastische & Ästhetische Chirurgie, Handchirurgie, Sportmedizin und Rettungsmedizin:

• Er ist ausgebildet an der Universität Göttingen (1994–2001), der Universität Frankfurt am Main (Promotion 2001 mit einem elektrophysiologischen Thema zur Vorhofflimmertherapie) und der Med. Hochschule Hannover (2001–2012, chirurgische Facharztausbildung und klinische Tätigkeit).
• Er ist Fellow des American College of Surgeons (FACS), Präsident der deutschsprachigen int. Gesellschaft für Stoßwellentherapie (DIGEST), CCO der Int. Society of Musculoskeletal Shockwave Therapy (ISMST) und Principal Reviewer u. a. für das American Journal of Sports Medicine (AJSM). Prof. Knobloch hat sechs Bücher und mehr als 270 Peer-Review-Arbeiten veröffentlicht.
Hochauflösender Ultraschall in der Sportpraxis
Wie kamen Sie zur Sonographie?
„Ultraschallsysteme am Bewegungsapparat und am Herzen haben mich die letzten 20 Jahre sehr intensiv begleitet. Ich habe 2001 meine herz- und gefäßchirurgische Facharztausbildung bei Prof. Haverich an der Med. Hochschule Hannover begonnen, wo ich bereits mit den Duplexverfahren die Carotiden und auch die Beinarterien prüfte. Eines meiner Forschungsprojekte war beginnend 2002 die Mikrozirkulation, die ich mit einem kombinierten Laser-Doppler- und Spektrophotometriesystem, dem Oxygento-see von LEA Medizintechnik, untersuchte – zunächst in der Herzchirurgie die Brustwanddurchblutung nach IMAEntnahme bei der Bypass-Operation und später die Handperfusion nach Radialisentnahme als arteriellem Graft.
Nach meinem Wechsel 2004 in die Unfallchirurgie habe ich z. B. mit einem portablen australischen Ultraschallsystem (USCOM) als Hubschraubernotarzt am Notfallort Hämodynamikmessungen mit Bestimmung des Herzzeitvolumens durchgeführt.
Das vorgenannte Oxygen-to-see-System habe ich dann an Achillessehnen eingesetzt und entdeckte 2005 einen gesteigerten Blutfluss bei midportion-Achillodynie, was im American Journal of Sports Medicine seinen Platz fand.“
Welche Systeme haben Sie begleitet?
„Für die klinische Sonographie am Bewegungsapparat habe ich in der MHH ein Toshiba System eingesetzt, bei dem ich einen hervorragenden Power-Doppler-Modus vorfand, um die Neogefäße an entzündeten Sehnen zu visualisieren. Ich habe 2005 begonnen, Power-Doppler-gesteuerte Sklerosierungen dieser Neogefäße mit Polidocanol vorzunehmen. Daher habe ich mich zu Beginn meiner Sportpraxis 2012 aufgrund der Power-Doppler-Sonographie für ein Toshiba Nemio System mit einem Linearschallkopf und einer Hockeysticksonde für die Handchirurgie entschieden. Dieses habe ich auch für die dynamische Sonographie von A1-Ringbandstenosen mit großem Gewinn eingesetzt.“
INTERVIEW // ULTRASCHALL // Aplio i800
Prof. Dr. Karsten Knobloch aus Hannover
56 // VISIONS 31
Warum haben Sie sich jetzt für ein Highend-Ultraschallsystem entschieden?
„2017 habe ich zum ersten Mal in einer Teststellung den weiterentwickelten Superb Micro Vascular Imaging (SMI) Modus getestet und war schon begeistert. Ich wollte aber zusätzlich eine verlässliche und einsetzbare quantitative Scherwellenelastographie, wie sie jetzt im Aplio i800 System zu finden ist. Außerdem sind die Matrixschallköpfe bis 33 MHz für mich von immenser Bedeutung.“
Wer sind Ihre Patienten in der Sportpraxis?

„Der typische Patient in meiner Sportpraxis ist männlich (in 70 % der Fälle), im mittleren Alter von 52 Jahren und stellt sich mit einem Achillessehnenproblem vor. Er ist Hobbyläufer oder Fußballer oder Tennisspieler und sucht mich häufig für eine Zweit-, Dritt- oder Viertmeinung zur gezielten Diagnostik und Therapie der Achillessehnenbeschwerden auf.“
Sie bieten in Ihrer Praxis Spitzendiagnostik für Sportler aus ganz Deutschland an. Was sind die häufigsten diagnostischen Fragestellungen für den Ultraschall?
„Für gewöhnlich suchen mich Patienten mit Sehnenproblemen auf, vornehmlich der Achillessehne, der Patellasehne, der plantaren Faszie am Fuß, aber auch weiterer Sehnen an der unteren Extremität wie der Quadricepssehne oder der Peronealsehnen. An der oberen Extremität sind die Supraspinatussehne und die lange Bizepssehne an der Schulter, die gemeinsame Extensorensehne am lateralen Ellenbogen, die Flexor-carpi-ulnaris-Sehne beim Golferellenbogen und die Handsehnen streck- wie beugeseitig schmerzhaft. Nach der eingehenden Anamnese und der klinischen Untersuchung inklusive Funktions- und z. T. Krafttests führe ich dann eine umfassende Ultraschalluntersuchung unter Einsatz der Graustufensonographie, der unterschiedlichen Dopplermethoden und neuerdings auch der Scherwellenelastographie durch.“
Welchen Stellenwert hat die Hochfrequenzsonographie in Ihrer Praxis?
„Bei jedem von mir sonographierten Patienten setze ich die Power-Doppler-Sonographie und den SMI-Modus zur präzisen Beurteilung der Mikrogefäßarchitektur ein. Die PowerDoppler-kontrollierte Injektionstherapie bei Tendinopathien –sei es mit Polidocanol zur Sklerosierungsinjektion oder der Hyaluronsäure Ostenil Tendon – ist eine ganz wesentliche Therapieoption für Tendinopathien an der oberen und unteren Extremität in meiner Sportpraxis.“
Beeinflusst die neue Technik Ihre therapeutische Vorgehensweise?
„Ja, durch das SMI in Ergänzung zur Power-Doppler-Sonographie kann ich noch präziser die Neovaskularisation visualisieren, wobei ich mir zunächst in SMI colour, dann auch im SMI-monochrome-Modus – ähnlich einer in-vivoMikroskopie – ein genaues Mikrogefäßbild mache.“
VISIONS 31 // 57 © 2021 C ANON MEDICAL SYSTEM S
„Bei jedem von mir sonographierten Patienten setze ich die Power-DopplerSonographie und den SMI-Modus zur präzisen Beurteilung der Mikrogefäßarchitektur ein.“
Welchen Nutzen haben Ihre Patienten davon?

„Je präziser und quantitativer die Diagnose, desto besser lässt sich einerseits der Schweregrad beispielsweise einer Achillodynie einschätzen und umso besser können prognostische Einschätzungen und therapeutische Empfehlungen gegeben werden.“





Wie bewerten Sie die neuen Möglichkeiten der quantitativen Beurteilung der Gewebeelastizität für den Bewegungsapparat?
„Für mich ist die quantitative Scherwellenelastographie, die es mir nichtinvasiv ermöglicht, eine Aussage über die Gewebehärte zu generieren, offen gesagt eine Offenbarung. Ich lerne mit jedem untersuchten Patienten die Elastizität der untersuchten Sehne in m/s besser kennen und beobachte auch den Einfluss meiner therapeutischen Bemühungen mit den unterschiedlichen von mir eingesetzten Techniken.“
Eröffnung der SPORTPRAXIS am 1. Dezember 2012. Im Bild: Prof. Knobloch mit Philipp Bargfrede, SV Werder Bremen.
Kevin DeBruyne, derzeit Manchester City.
58 // VISIONS 31
Alex Meier, ehemals Eintracht Frankfurt, jetzt U16-Trainer Eintracht Frankfurt.
In puncto Bildgebung und Diagnostik sind Sie sehr innovativ unterwegs. Welche Entwicklungen wünschen Sie sich in naher Zukunft für den Ultraschall?









„Ich darf kurz ergänzen – auch in der Therapie bin ich sehr innovativ, setze nichtinvasive Techniken wie die fokussierte und radiale Stoßwellentherapie, die Low Level Lasertherapie, neuerdings auch die ultraschallgestützte galvanische Elektrolyse (Gymna Acure 8000) wie auch die extrakorporale Magnetotransduktion (EMTT) mit dem Magnetolithsystem ein. Von der Sonographie erhoffe ich mir in der Zukunft u. a. eine Fusion mit Schichtbildverfahren, insbesondere mit der Cone Beam CT, die ich als DVT in meiner Praxis für die Knochenbildgebung einsetze. Des Weiteren erhoffe ich mir weitere Verbesserungen in der Scherwellenelastographie oberflächennah <1 cm, wo mitunter Grenzen in der Erfassung der Scherwelle auftauchen. //



 Spindelförmig verdickte midportion Achillestendinopathie auf 10,6 mm ap-Durchmesser vs. 6,8 mm auf der gesunden Gegenseite.
Die Scherwellenelastographie zeigt die pathologische Elastizität mit 7,2 m/s (links) vs. 3,8 m/s (rechts).
Spindelförmig verdickte midportion Achillestendinopathie auf 10,6 mm ap-Durchmesser vs. 6,8 mm auf der gesunden Gegenseite.
Die Scherwellenelastographie zeigt die pathologische Elastizität mit 7,2 m/s (links) vs. 3,8 m/s (rechts).
„Für mich ist die quantitative Scherwellenelastographie, die es mir nichtinvasiv ermöglicht, eine Aussage über die Gewebehärte zu generieren, offen gesagt eine Offenbarung."
Prof. Dr. Karsten Knobloch, FACS
Prof. Knobloch 2005 als Notarzt im RTH Christoph 4 bei portabler Hämodynamikmessung mit dem USCOM-System.
M.
Osgood Schlatter, dargestellt mit SMI und Scherwellenelastographie. Nachweis der reduzierten Elastizität der distalen Patellasehne an der noch nicht vollständig verknöcherten Tuberositas tibiae.
VISIONS 31 // 59 © 2021 C ANON MEDICAL SYSTEM S
Ellenbogen eines Golfpatienten nach dreimonatiger Schmerzdauer. Darstellung der entzündeten M. flexor carpi ulnaris Sehne mit SMI. Die Sehne zeigt eine normale Elastizität.
Ein Plädoyer für hochwertige Ultraschallausrüstung in der neurologischen Praxis
Wenn Sie als Neurologe Besuch von Profi-Handwerkern bekommen, sind Sie in der Regel beeindruckt von deren Geräteausstattung mit meist High-End-Geräten namhafter deutscher oder Schweizer Hersteller.
Dagegen mutet ein Blick auf die Ultraschallausstattung in der eigenen Praxis oft ernüchternd an. Warum sind hier viele Kollegen so „sparsam“ unterwegs und ist das wirklich sinnvoll?
Bislang bestand die Anwendung des Ultraschalls in der neurologischen Praxis ausschließlich im vaskulären Ultraschall der hirnversorgenden Gefäße (also v. a. extra-/intrakranielle Doppler- und Duplexsonographie). Mit der Nerven- und Muskelsonographie hat sich in den letzten Jahren jedoch eine weitere Anwendungsmöglichkeit erschlossen, die insbesondere auch die Anschaffung qualitativ höherwertiger Geräte sinnvoll bzw. sogar nötig macht. Abgesehen davon, dass sich mit einer höherwertigen technischen Ausstattung natürlich auch bessere Befunde und damit für den Patienten bessere und ggf. wichtige diagnostische und therapeutische Entscheidungen treffen lassen, sprechen auch wirtschaftliche Aspekte eigentlich klar für den Einsatz von Premium-Ultraschallsystemen.



Beispiel für den vaskulären Ultraschall
Extrakraniell lässt sich in der Regel auch mit älteren und einfacheren Geräten zumindest die Carotisbifurkation zuverlässig darstellen. Schwieriger sind oftmals bereits die distalen Abschnitte der A. carotis oder die A. vertebralis (inkl. deren Abgängen) darstellbar, was zudem durch ungünstige anatomische Verhältnisse/eine ungünstige anatomische Konstitution des Patienten nochmals erschwert werden kann. Intrakraniell ist mit älteren oder einfacheren Geräten häufig kein adäquates Schallfenster zu finden oder sind die intrakraniellen Gefäße nur schwierig und im Rahmen einer langwierigen Suche unter Optimierung des dürftigen Schallfensters darstellbar. Teilweise ist auch gar keine Untersuchung möglich, die mit leistungsstärkeren Geräten ggf. doch noch gelingen würde.
Aufgrund eigener Erfahrungen/Versuche mit unterschiedlichen Geräteklassen ist eine Zeiteinsparung pro Untersuchung von mind. 1 min bei Verwendung höherwertiger Geräte absolut realistisch. Bei konservativer Annahme von 150 Untersuchungen pro Quartal würde sich somit eine jährliche Zeitersparnis von ca. 10 h ergeben. Bei einem Umsatz/Stunde von 200 bis 300 € wäre dies eine Ersparnis von mind. 2.000 €.
Unser Gespräch mit Dr. Axel Schramm aus der neurologischen Gemeinschaftspraxis in Fürth.
Dr. Axel Schramm
INTERVIEW // ULTRASCHALL // NeuroPraxis Fürth 60 // VISIONS 31
Circulus arteriosus inkl. sehr guter Sicht auf den Hirnstamm. A. und V. vertebralis.
seits ist eine Untersuchung bei Standardanwendungen wie dem Karpaltunnel- und Sulcus-Ulnaris-Syndrom (inkl. Auswertung der Nervenquerschnittsfläche in 2 Ebenen) mit entsprechender technischer Ausstattung mit 1–2 min sehr schnell durchführbar! Bei Privatpatienten lassen sich in ca. 2–3 min z. B. der N. medianus und die Medianus-versorgte Thenarmuskulatur darstellen, was sich mit den Ziffern 1x 410 und 3x 420 (Nervensonographie rechts, links; Muskelsonographie rechts, links) abbilden lässt.

Dies generiert bei 2,3-fachem bzw. aufgrund der Verwendung spezieller hochauflösender Ultraschallsonden ggf. zu rechtfertigendem 3,5-fachem Steigerungssatz Einnahmen von 58,97 € (410 = 26,81 € + 3x 420 = 32,16 €) bzw. 89,76 € (410 = 40,80 € + 3x 420 = 48,96 €). Bei der Anwendung des NMUS lassen sich also bereits bei 1–2 Privatpatienten im Monat lukrative Zusatzeinnahmen generieren.
Beispiel
den Nerven- und Muskelultraschall (NMUS)
Die Etablierung einer neuen Ultraschallanwendung, wie z. B. des Nerven- und Muskelultraschalls, in der Praxis führt natürlich zunächst immer auch zu einer besseren Geräteauslastung und damit zur Reduktion von Anschaffungs- und laufenden Kosten.
Allerdings ist die Vergütung insbesondere bei Kassenpatienten mit ca. 6,15 € (Ziffer 33081 ohne Zertifizierung durch die KV) bzw. 7,91 € (Ziffer 33100 mit Zertifizierung durch die KV) eher gering. Anderer-

„Eine jährliche Zeiteinsparung im vaskulären Bereich von mind. 10 h bei Verwendung höherwertiger Geräte ist absolut realistisch!“
für
N. medianus am Unterarm und vor dem Karpaltunnel bei CTS.
VISIONS 31 // 61 © 2021 CANON MEDICAL SYSTEMS
Dr. Axel Schramm.
Der wirtschaftliche Benefit der Methode liegt aber nur zum Teil in der Möglichkeit, weitere Leistungen abzurechnen. Mit der Methode lassen sich insbesondere neurophysiologische Untersuchungen einsparen (z. B. schneller Ausschluss eines sowieso unwahrscheinlichen Karpaltunnelsyndroms) oder gezielter und damit effektiver einsetzen (z. B. Vorselektion von Muskeln für eine in der Regel aufwändige EMG-Untersuchung).
Konservative Gesamtrechnung für den Nerven- undMuskelultraschall
Nervenläsionen bzw. -verletzungen detektieren und damit zuverlässige Entscheidungen hinsichtlich der weiteren, ggf. operativen Therapie treffen.
Last, but not least ist zudem hinzuzufügen, dass die Verwendung technisch höherwertiger Geräte auch mit einem erheblichen Zugewinn an Spaß und Erleichterung bei der Arbeit verbunden ist –und das gilt nicht nur für Handwerkergeräte namhafter deutscher/ Schweizer Hersteller, sondern insbesondere auch für den Ultraschall in der neurologischen Praxis.
Vielen Dank für das Gespräch! // 1–2 Privatpatienten im Monat ergeben einen Umsatz von ca. 1.000 € im Jahr.
Die kassenärztlichen Leistungen über die Ziffern 33081 und 33100 generieren lediglich ca. 25 € pro Woche und ergeben einen Jahresumsatz von ca. 1.000 €.
Durch Einsparung von neurophysiologischen Untersuchungen im Umfang von ca. 10 Arbeitsminuten pro Woche (entsprechend 400 min oder 6,5 h/Jahr) sind das bei einem Stundensatz von 200 €/h etwa 1.300 € Einsparungen im Jahr.
In der Summe ergeben sich für den Nerven- und Muskelultraschall etwa 3.000 € Einnahmen im Jahr.
Für beide Anwendungsbereiche zusammen ergeben sich bei sehr konservativer Rechnung realistische Einsparungen und Zusatzerlöse von gut 5.000 € im Jahr. Legt man eine Gerätelaufzeit von 8 Jahren zugrunde, so lassen sich bei der Anschaffung eines neuen Ultraschallgeräts Mehrinvestitionskosten von bis zu 40.000 € rechtfertigen.
Diese Modellrechnungen sollen dabei jedoch kein Aufruf zur Gewinnoptimierung sein, sondern lediglich zeigen, dass Investitionen in eine verbesserte Ultraschallausrüstung und Diagnostik sich wirtschaftlich zumindest amortisieren.
Hinzu kommt wie gesagt – und für uns als Ärzte natürlich letztlich am wichtigsten –, dass eine verbesserte Diagnostik in erster Linie dem Patienten zugute kommt. Im vaskulären Bereich bezieht sich das insbesondere auf eine optimierte Detektion und Graduierung von Gefäßstenosen sowie eine verbesserte Risikoeinschätzung und Beratung hinsichtlich der weiteren Therapie. Im Bereich Nerven- und Muskelultraschall lassen sich durch die hochauflösende Sonographie insbesondere auch kleine und komplexe
Dr. Axel Schramm ist seit Mitte 2016 in eigener neurologischer Gemeinschaftspraxis in Fürth tätig.

Als langjähriger Oberarzt und Leiter des Neurophysiologischen Labors der Neurologischen Universitätsklinik Erlangen hat er die Nervenund Muskelsonographie (NMUS) dort etabliert und sich auch wissenschaftlich mit dem Thema befasst.
Als Seminarleiter für Nerven- und Muskelsonographie der Dt. Gesellschaft für Ultraschall in der Medizin (DEGUM) hält er regelmäßig Vorträge und Kurse zum Thema NMUS und ist an der Fortentwicklung der Methode inkl. der federführenden Etablierung von 3D-Verfahren interessiert. Der klinische Schwerpunkt in der eigenen Praxis liegt u. a. in der neurosonologischen Diagnostik (vaskulär, NMUS) sowie insbesondere in Kombination mit der Neurophysiologie.
„Mit der Hochfrequenzsonographie lassen sich insbesondere neurophysiologische Untersuchungen einsparen oder gezielter und effektiver einsetzen.“
62 // VISIONS 31
Dr. Axel Schramm.
Veranstaltungen & Workshops 2021/22
2021
21.08. Berlin
BNK Niederlassungsseminar
28.08. Hannover
Niedersächsischer Gynäkologentag
02. – 04.09. Münster
61. DGH-Kongress
03. – 04.09. Leipzig
3. Anwenderseminar Muskel- und Nervensonographie
15. – 18.09. Stuttgart
73. Kongress der Deutschen Gesellschaft für Urologie
13. – 18.09. Leipzig
Viszeralmedizin 2021
17. – 18.09. Würzburg
CEUS in Dresden IX
30.09. – 02.10. Landshut/Essenbach
73. Jahrestagung und MTRA-Tagung der Bayerischen Röntgengesellschaft 2021
03.10. Hofheim, Digital
22. Hofheimer Tierärztetag und 8. Tagung für Tiermedizinische Fachangestellte
06. – 08.10. Digital
56. Jahrestagung der Deutschen Gesellschaft
für Neuroradiologie e.V. (neuroRAD 2021)
06. – 09.10. Berlin, Hybrid
Kongress für Kinder- und Jugendmedizin 2021 (DGKJ)
22. – 23.10. Hamburg
Uro-Andrologisches Symposium –Meet the Experts
27. – 29.10. Wien
Ultraschall 2021 (DLT)
03.11. Stuttgart
Canon SONOSALES
04. – 05.11. Dortmund
13. RadiologieKongressRuhr
04. – 06.11. Rostock-Warnemünde
Ultraschall in Warnemünde 2021
06.11. München
Canon SONOSALES
10.11. Frankfurt
Canon SONOSALES
12.11. Neuss
Canon SONOSALES
13.11. Chemnitz
9. Mitteldeutsche Tagung Neonatologie und Pädiatrische Intensivmedizin (MITANPI)
18. – 20.11. Berlin
DVG-Vet-Congress 2021
20.11. Rheine
12. Rheiner Symposium für Gynäkologie und Perinatalmedizin
20.11. Essen
Canon SONOSALES
27.11. Hamburg
Canon SONOSALES
04.12. Dresden
Canon SONOSALES
09. – 11.12. Berlin, Hybrid EuroEcho 2021
2022
14. – 15.01. Köln
Update RSNA
22.01. Dortmund
DEGUM Refresher-Kurs Dopplersonographie
11. – 12.02. Hamburg
04. – 05.02.
Radiologiekongress Nord
Baden-Baden
Frühjahrskurse der VSRN
27. – 26.06. Wiesbaden, Hybrid
103. Deutscher Röntgenkongress
Immer aktuell – online unter: https://de.medical.canon/events/
Präsenz Hybrid Digital
Termine // CT, MR, Röntgen und Ultraschall // 2021/22
DATUM ORT/VERANSTALTUNG DATUM ORT/VERANSTALTUNG
VISIONS 31 // 63 © 2021 C ANON MEDICAL SYSTEM S
Gelenkerkrankungen im Kindesalter
Privatdozent Dr. Daniel Windschall leitet die Klinik für Kinder- und Jugendrheumatologie im Rheumatologischen Kompetenzzentrum Nordwestdeutschland im St. Josef-Stift in Sendenhorst bei Münster, eine von zwei deutschen Spezialkliniken für kindliches Rheuma. Im Interview spricht er darüber, welchen diagnostischen Nutzen seine Abteilung durch den Einsatz des Highend-Ultraschallsystems Aplio i800 für Diagnostik, Therapie und Monitoring erfährt.
Herr Dr. Windschall, Sie leiten die Klinik für Kinder- und Jugendrheumatologie im St. Josef-Stift Sendenhorst. Was ist das Besondere an Ihrem Zentrum?
Wir gehören bundesweit zu den führenden Schwerpunktzentren, die Kinder und Jugendliche mit rheumatischen Erkrankungen umfassend behandeln und betreuen. Unsere Patienten kommen aus dem gesamten Bundesgebiet. Wir halten 49 stationäre Betten und ein sehr großes interdisziplinäres Team mit 13 Ärzten, einer spezialisierten Pflege, mit Psychologen, Physiotherapeuten, Ergotherapeuten und Erziehern vor. Auch eine eigene Orthopädiewerkstatt gehört dazu. Wir behandeln in der Kinderrheumaklinik stationär rund 1600 Patienten pro Jahr und zirka 2100 weitere Patienten kommen ambulant hinzu. Für lokale Gelenkbehandlungen, wie zum Beispiel Cortisoneinspritzungen und Punktionen, stehen eigene OPKapazitäten und Eingriffsräume zur Verfügung. Da Rheuma eine chronische Krankheit ist, ist eine allumfassende Versorgung besonders wichtig. Bei den kleinen Kindern wohnen die Eltern direkt mit im Patientenzimmer, aber auf dem Gelände gibt es auch ein Wohnheim für Eltern. Auch eine Klinikschule mit Lehrerteam ist für längere Aufenthalte vor Ort. Außerdem bieten wir Schulungen für Kinder und Eltern an, damit wir
die Patienten gut gerüstet in den Alltag entlassen können. Auch der SelbsthilfeVerein „Bundesverband Kinderrheuma“ hat ein eigenes Büro bei uns im Haus. Im Rahmen unseres Rheumatologischen Kompetenzzentrums besteht auch eine optimale Zusammenarbeit mit der internistischen Rheumatologie beim Übergang der Jugendlichen in das Erwachsenenalter (Transition) und mit der Klinik für Rheumaorthopädie.

Wie unterscheidet man bei Kindern zwischen harmlosen Gelenkbeschwerden und chronisch entzündlichen Gelenkerkrankungen?
Es gibt zum Beispiel so genannte „Wachstumsschmerzen“ oder auch nächtliche Beinschmerzen, die bei Kindern zwischen drei und zwölf Jahren nicht selten auftreten. Dabei sind die Gelenke unauffällig und nicht entzündet. Gegen diese nächtlichen Bein
INTERVIEW // ULTRASCHALL // Aplio i800
64 // VISIONS 31
„Beim kindlichen Rheuma lassen sich die Beschwerden lokalisieren.“
schmerzen helfen zum Beispiel Wärme, Massagen und Lockerungen der Muskeln. Aber die Beschwerden haben nichts mit Rheuma zu tun. Auch andere Gelenkbeschwerden, wie zum Beispiel Belastungsschmerzen, orthopädische Ursachen oder auch chronische Schmerzen am kindlichen Bewegungsapparat sind nicht durch eine Entzündung verursacht.
Typischerweise wachen Kinder mit Rheuma häufig morgens mit einer so genannten Morgensteifigkeit auf und sind stark in der Bewegung beeinträchtigt. Die Gelenke können angeschwollen und überwärmt sein. Beim kindlichen Rheuma lassen sich die Beschwerden meistens klar lokalisieren, bei den so genannten Wachstumsschmerzen sind es hingegen eher diffuse Schmerzen, die sich nur schwer eindeutig zuordnen lassen.
Was sind die Ursachen für rheumatische Erkrankungen im Kindesalter?
Es handelt sich um eine Fehlreaktion des Immunsystems, bei der der eigene Körper zum Beispiel im Gelenk Entzündungen produziert. Deshalb werden diese Erkrankungen auch Autoimmunerkrankungen genannt. Auch bei der JIA (juvenile idiopathische Arthritis) kann es zu Entzündungen verschiedener Gelenke kommen. Warum das
passiert, ist allerdings noch nicht eindeutig geklärt. Aus diesem Grund lassen sich diese Erkrankungen auch noch nicht kausal therapieren.
Welche Rolle spielt der Ultraschall bei Ihnen in der Diagnostik?
Der kindliche Gelenkultraschall hilft, die Gelenke und Sehnen viel genauer unter die Lupe zu nehmen und zum Beispiel Gelenk oder Sehnenentzündungen besser von Verletzungen oder anderen Ursachen zu unterscheiden. Durch die Entwicklung der Ultraschalltechnik im Nahbereich können insbesondere Gelenke von Kindern hervorragend geschallt werden. Da die Gelenke von Kindern im Ultraschall anders als die Gelenke von Erwachsenen aussehen, ist es dabei aber sehr wichtig, dass die behandelnden Ärzte entsprechend ausgebildet sind und ausreichend Erfahrung haben. Unser Team hat sich in den letzten Jahren wesentlich an der Entwicklung von Standards für die kindliche Gelenkultraschalluntersuchung in mehreren Arbeitsgruppen eingebracht. Bei entzündeten Gelenken kann man mit sensitiven Farbdopplerverfahren sehr früh und genau Entzündungsgefäße bei Kindern entdecken, die von den normalen Blutgefäßen unterschieden werden müssen. Neben der klinischen Untersuchung ist der Ultraschall ein
äußerst wichtiges Mittel zur Diagnose von Gelenkentzündungen.
Was sind denn die Vorteile des Verfahrens für Sie?
Die Ultraschalluntersuchung ist schnell, sie tut nicht weh und lässt sich gut am Monitor verfolgen – das alles ist besonders bei der Arbeit mit Kindern von Vorteil. Darum ist der Ultraschall bei uns in der Kinderrheumatologie mittlerweile auch eines der bildgebenden Mittel der Wahl. Ein großer Vorteil der Ultraschalldiagnostik gegenüber dem Röntgen ist die Möglichkeit der Weichteildarstellung. Außerdem ist die Ultraschalluntersuchung dynamisch. Das heißt, ich kann während der Untersuchung mit dem Schallkopf über das gesamte Gelenk fahren und ganz gezielt nach Auffälligkeiten oder Entzündungsproblematiken suchen. Leider wird die Diagnose kindliches Rheuma nicht selten viel zu spät gestellt und es werden Frühzeichen übersehen. Insbesondere geht man bei kindlichen Gelenkschmerzen viel zu häufig von einer Verletzung oder Überbelastung aus, bevor an die Diagnose kindliches Rheuma gedacht wird. Darum haben die Patienten häufig schon eine regelrechte Odyssee an Untersuchungen hinter sich, bevor sie beim Kinderrheumatologen vorgestellt werden.

VISIONS 31 // 65 © 2021 C ANON MEDICAL SYSTEMS //
Gibt es Ausnahmen, bei denen Sie trotzdem auf die komplementäre Bildgebung von MRT und Röntgen setzen?
Ja. Etwa bei der Untersuchung der Kiefer und der Iliosakralgelenke. Da setzen wir auf die Magnetresonanztomographie. Für die Röhre müssen wir kleine Kinder allerdings in der Regel sedieren. Im chronischen Verlauf des Rheumas, wenn die Gelenke auch knöchern verändert werden, kann auch eine Röntgenaufnahme notwendig sein. Genauso auch bei bestimmten Differentialdiagnosen, wenn wir beispielsweise einen Knochentumor ausschließen wollen.



Sie haben sich in Ihrer Klinik für das Highend-Ultraschallsystem Aplio i800 entschieden. Was zeichnet dieses Gerät besonders aus?
Es ist ein HighendGerät mit einer TopAuflösung. Das Aplio i800 lässt sich mit hochfrequenten MatrixSonden ausstatten, mit deren alldimensionaler Fokussierung man sehr hohe Ortsauflösungen erzielen kann. Insbesondere im Hinblick auf den rheumatologischen Schwerpunkt in unserem Institut ist eine hoch auflösende und artefaktreduzierte Darstellung der Gelenke und der feinen Sehnenstrukturen sehr
„Bei entzündeten Gelenken kann man mit sensitiven Farbdopplerverfahren sehr früh und genau Entzündungsgefäße bei Kindern entdecken.“
66 // VISIONS 31
PD Dr. Daniel Windschall
wichtig für eine suffiziente Ultraschalldiagnostik. Bei einer Entzündung kommt es zu einer Schwellung und vermehrten Durchblutung der Gelenkschleimhaut. Mit dem hochsensitiven Superb Micro Vascular Imaging Farbdoppler (SMI) am Aplio i800 können wir sehr langsame Blutflüsse in den Gelenken und in der Gelenkinnenhaut darstellen und so eine Gelenkentzündung genau lokalisieren.
Was bringt Ihnen diese Darstellung konkret für die Therapie?
Wenn wir eine gesteigerte Durchblutung der Gelenkschleimhaut sehen, ist das ein wichtiges Kriterium für eine aktive Gelenkentzündung. Je genauer wir akute Entzündungen lokalisieren
können, desto gezielter können wir zum Beispiel auch Punktionen durchführen.
Was zeichnet das Aplio i800 noch aus? Sicherlich die hohe BBildauflösung, die uns die Strukturen sehr gut unterscheiden lässt. Gerade bei Kindern profitieren wir stark von den kleinen HochfrequenzApplikatoren. Die kleinen Schallköpfe können wir zum Beispiel auch bei ultraschallgeführter Gelenkpunktionen an den kleinen Extremitäten gut verwenden. Das erleichtert uns die sichere Nadelführung. Mittlerweile setzen wir Ultraschall für Diagnose, Therapie und auch für das Monitoring, das heißt für die Beobachtung des Verlaufs der Krankheit, ein.
Wie müsste Ihr Wunsch-Ultraschallsystem der Zukunft aussehen?
Die Qualität ist schon sehr gut. Die Auflösung entwickelt sich immer weiter nach oben. Ich würde mir für die Zukunft wünschen, dass man auch bei den Canon Geräten den Schallkopf ohne Kabel in der Hand halten kann. Eine solche Vernetzung von Schallkopf zu Gerät via Bluetooth wäre zum Beispiel für die Gelenkpunktion sehr hilfreich. Das würde die Handhabung noch flexibler machen.
Vielen Dank für das Gespräch! //
Zur Person Kindliches Rheuma
• 2019 trat Privatdozent Dr. Daniel Windschall die Chefarztnachfolge von Dr. Gerd Ganser in der Klinik für Kinder- und Jugendrheumatologie am Rheumatologischen Kompetenzzentrum Nordwestdeutschland am St. Josef-Stift Sendenhorst bei Münster an.
Seit 2011 ist PD Dr. Daniel Windschall Dozent an der Martin-Luther-Universität Halle-Wittenberg, an der er 2017 im Fachgebiet Kinderrheumatologie habilitierte.
• 2011 gründete er mit Kollegen die Kommission Bildgebung der Gesellschaft für Kinder- und Jugendrheumatologie. Als Sprecher der Kommission initiierte Windschall mit seinen Kollegen zahlreiche Studien, Fortbildungen und Kurse zur Verbesserung der Qualitätsstandards in der kindlichen Gelenksonografie.
• Daniel Windschall hat als aktives Mitglied der Sektion Pädiatrie und des Arbeitskreises Bewegungsorgane der DEGUM die höchste Qualifikation, DEGUM III, sowohl für die Pädiatrie als auch für den Arbeitskreis Bewegungsorgane. In der Sektion Pädiatrie ist Windschall verantwortlich für die Kurszertifizierungen. Auch international ist Windschall mit zahlreichen Ultraschallprojekten aktiv. Er ist Ultraschalllehrer der europäischen Rheumagesellschaft EULAR und Mitglied der Ultraschall-Forschungsgruppe der OMERACT (Outcome Measures in Rheumatology Clinical Trials) sowie der Arbeitsgruppe Bildgebung der europäischen Gesellschaft für Kinderrheumatologie (PReS). Kürzlich verfasste er mit internationalen Kollegen einen interaktiven Online-Lehratlas für die kindliche Gelenksonografie (www.Ped-MUS.com) sowie ein englischsprachiges Lehrbuch zu dieser Thematik.
• Bei einem von 1000 Kindern pro Jahr tritt eine chronische Gelenkentzündung auf, die man kindliches Rheuma nennt
• In Deutschland gibt es zwei Spezialkliniken: das Deutsche Zentrum für Kinder und Jugendrheumatologie in GarmischPartenkirchen und die Klinik für Kinder und Jugendrheumatologie im St. JosefStift Sendenhorst
• Im St. JosefStift Sendenhorst werden alle Rheumakrankheiten von Kindern und Jugendlichen behandelt. Ein Schwerpunkt liegt auf der juvenilen idiopathischen Arthritis (JIA) mit ihren verschiedenen Unterformen
• Die Klinik ist Teil des Rheumatologischen Kompetenzzentrums Nordwestdeutschland im St. JosefStift Sendenhorst und arbeitet eng mit den Kliniken für Rheumatologie und Rheumaorthopädie zusammen
„Hochfrequenzsonden mit kleinen Applikatoren sind für die Arbeit mit Kindern besonders geeignet.“
VISIONS 31 // 67 © 2021 C ANON MEDICAL SYSTEM S
Traumatische Nervenläsionen –über den Einsatz des Nervenultraschalls
Traumatische Nervenläsionen haben eine Inzidenz von etwa 13 bis 23 pro 100 000 Einwohner pro Jahr und ihr Einfluss auf die Alltagsfunktionen ist für das weitere Leben der oft jungen Patienten sehr bedeutsam.1 Die Betroffenen befinden sich in Behandlung zahlreicher Fachärzte und Therapeuten (Hausärzte, Internisten, Neurologen, Chirurgen, Orthopäden, Schmerztherapeuten, Physiotherapeuten, Radiologen und anderer). Allen gemein ist die Herausforderung der Planung des weiteren Prozederes, für die eine suffiziente Einschätzung der Schädigung und ihrer Regenerationsfähigkeit sowie eine Prognose notwendig sind. In dieser frühen Phase einer traumatischen Nervenverletzung werden die Weichen gestellt: Wird eine Restitutio ad integrum erreichbar oder wie hoch wird das Ausmaß der bleibenden Behinderung für das weitere Leben sein?
Die Regenerationsfähigkeit der Nerven ist unterschiedlich und zudem u. a. abhängig von Schweregrad und Art der Läsion. Bei der Regeneration spielt der Faktor Zeit eine entscheidende Rolle. Im Falle einer unzureichenden Regeneration können operative Therapien zum Einsatz kommen. Hierfür liefert der Nervenultraschall als bildgebendes Verfahren zeitnah wertvolle und nicht selten entscheidende Informationen in Ergänzung zu Klinik und Elektrophysiologie. Damit wird eine frühe Optimierung der Therapieplanung mit unmittelbarem Einfluss auf das Outcome ermöglicht.
Nervenultraschall zur Einschätzung der Nervenläsion nach Trauma
Während Klinik und elektrophysiologische Untersuchungen (wie EMG, Neurographie, evozierte Potenziale etc.) häufig Hinweise auf Art (z. B. axonal oder demyeliniseriend, keine Reizantwort) und Schwere einer Nervenläsion sowie auf ihre Lokalisation liefern können, dient der Nervenultraschall dazu, Läsionsart und -höhe zu bestimmen bzw. zu präzisieren. Je höher die Auflösung ist, die Ultraschallgerät und Schallkopf ermöglichen, desto präziser kann die Läsion be-
urteilt werden. Auch für die Untersuchung von Kindern eignet sich der Nervenultraschall besonders, da die elektrophysiologische Untersuchung schmerzhaft sind und hier oft nicht ausreichend durchführbar oder auswertbar ist.
Der hochauflösende Ultraschall ist ohne Strahlenbelastung, im Vergleich zum MRT beispielsweise, breit verfügbar und kostengünstig. Mit einer guten Ausstattung ist eine hohe Auflösung erreichbar und die Mehrheit der peripheren Nerven für den Ultraschall zugänglich (hochfrequenter Linearschallkopf mit 12–24 MHz, für einige Regionen Konvexschallkopf mit bis zu 9 MHz) 1. Erfahrungsgemäß sind jedoch Ultraschallfrequenzen ab 18 MHz sinnvoll für die suffiziente Beurteilung, insbesondere die Faszikel sind erst ab 18 MHz beurteilbar. Auch kutane Nerven sowie kleine Nerven der Halsregion lassen sich nur mit hochfrequenten Sonden beurteilen, hier sind 24-MHz-Linearschallköpfe ideal. Die Hirnnerven und die Nerven des Plexus cervicalis sind abschnittsweise darstellbar. Die Armnerven lassen sich von axillär bis distal zu den Fingerendgliedern kontinuierlich in Längs- und Querschnitt darstellen. Durch die 24-MHz-Sonden sowie hochauflösende Hockeystick-Sonden lässt sich die Darstellung der
INTERVIEW // ULTRASCHALL // Traumatische Nervenläsionen
Dr. med. Alexandra Borchert, Fachärztin für Neurologie, Aachen
68 // VISIONS 31
„In der Akutphase einer Verletzung vor Abschluss der Waller’schen Degeneration (etwa zwei Wochen) ist die Aussagekraft der Elektrophysiologie limitiert, sodass hier dem Nervenultraschall eine besondere Rolle in der kontrollierten Therapieplanung zukommt.“
kleinen Nerven der Handgelenksregion und der Finger deutlich optimieren. Auch die Beurteilung der Gefäße mittels SMI (Superb-Micro-Vascular-Imaging) ist hier sehr zielführend. SMI lässt sich zudem für die Beurteilung der Vaskularisation der Nerventumore oder entzündlich veränderter Regionen einsetzen. Auch die infraklavikulären und supraklavikulären Plexusanteile sind bis auf einen nicht einsehbaren Abschnitt hinter der Klavikula beurteilbar. Ebenso können die zervikalen Wurzeln bis zu ihrem Eintritt in die Neuroforamina dargestellt werden. Nerven der Leistenregion sowie Intercostalnerven sind Abschnittsweise darstellbar. Die Beinnerven sind von proximal bis distal kontinuierlich detektierbar, ihr Ursprung im Plexus lumbosacralis aufgrund seiner tiefen Lage dagegen nicht. Die Qualität der Bildbeurteilung ist neben der Anatomie des Patienten und der Lokalisation des Nervs von der Frequenz des Schallkopfes, der Ausstattung des Gerätes und nicht zuletzt der Expertise des Untersuchers abhängig. So zeigen sich deutliche Unterschiede zwischen 15-MHz- und 18- oder gar 24-MHz- Schallköpfen, aber auch zwischen den Presets und den Ultraschallgeräten unterschiedlicher Leistungsstärke. Im Gegensatz zu anderen
1. Fokale Läsion des N. ulnaris nach Spickdrahtentfernung und distaler Humerusfraktur bei einem Kind. Im Bild sieht man deutlich den Knochendefekt nach Spickdrahtentfernung, der in Richtung Nerv verläuft. Der Nerv zeigt auf dieser Höhe eine fokale Auftreibung durch die mechanische Schädigung des mittlerweile entfernten Metalls. Die Echogenität ist hier herabgesetzt, der Nerv echoarm, die faszikuläre Struktur ist nicht vollständig differenzierbar, die Nervenquerschnittsfläche vergrößert.
2. Fokale Läsion des N. medianus bei einem Kind nach Humerusfraktur und Spickdrahtentfernung (unterer Pfeil). Hier zeigt sich im Längsschnitt ein deutlicher Wechsel der normalen faszikulären Nervenstruktur mit normaler Echogenität (links neben dem oberen Pfeil) und reduzierter Echogenität und Nervenschwellung mit tendenzieller Aufebung der faszikulären Struktur (rechts neben dem oberen Pfeil). Dieser Nerv erholte sich nach der Metallentfernung rasch und vollständig.
Verfahren ist eine dynamische Untersuchung möglich, die je nach Haltung der Extremität und Position des Nervs Symptomursachen detektieren kann, wie z. B. den Kontakt zwischen Nerv und Osteosynthesematerial, Knochenfragmenten, Hämatom oder Narbengewebe. Auch Artefakte durch eingebrachtes Metall sind im Ultraschall weniger einschränkend für die Beurteilung als in CT und MRT.
Aufgabe des sonographischen Befundes



Im ersten Schritt hat der Nervenultraschall die Aufgabe, Läsionsart und -höhe zu detektieren. Ist der Nerv in seiner Kontinuität erhalten? Sind die inneren und äußeren Strukturen des Nervs erhalten oder ganz oder teilweise verändert? Wie groß ist die Nervenquerschnittsfläche, wie groß die Längsausdehnung einer Läsion? Haben Strukturen in der Umgebung etwas mit der Nervenläsion zu tun? Gleichzeitig erhalten wir Rückmeldung von dem Patienten über Schmerz oder Hoffmann-Tinel-Zeichen durch Untersuchung der Region. Eine dynamische Untersuchung der betroffenen Region gibt Aufschluss über Kompression, fokale Adhäsion, Dislokation und andere Phänomene.

VISIONS 31 // 69 © 2021 C ANON MEDICAL SYSTEM S
Je genauer die Einordnung der Läsion gemäß der Einteilung nach Seddon und Sunderland1 gelingt, desto sicherer lässt sich das weitere Vorgehen planen. Hier reicht die Palette der Möglichkeiten von „Wait and See“ bis zur unmittelbaren operativen Therapie. Häufig finden sich heterogene Läsionen mit unterschiedlichem Schweregrad verschiedener Segmente nach Nerventrauma. Multisegmentale Läsionen entgehen der Elektrophysiologie leichter. Nicht selten werden nach Auswertung der elektrophysiologischen und klinischen Diagnostik, aufgrund der somatotopen Ordnung der Nervenfasern bereits früh im Nervenverlauf, weitere distal gelegene Läsionshöhen angenommen, als dies durch den Ultraschall oder beispielsweise die MR-Neurographie gezeigt werden konnte.1 Je höher die Auflösung des Ultraschallgerätes und Schallkopfes, desto sicherer können hier insbesondere intranervale Strukturen wie die Faszikel beurteilt werden.


Ein im Frakturspalt oder unter dem Osteosynthesematerial eingeklemmter Nerv sollte beispielsweise zügig operativ mobilisiert werden. Hier können weitere klinische und elektrophysiologische Kontrollen ohne Bildgebung die Gefahr eines schlechteren Outcomes erhöhen. Ist anhand der Konstellation ein Abwarten mit weiteren Kontrollen gerechtfertigt, können begleitende Physiotherapie und ggf. weitere Verfahren initiiert werden und engmaschige Kontrollen, beispielsweise alle vier bis sechs Wochen, sicherstellen, dass der Zeitpunkt für eine operative Intervention nicht verpasst wird. Häufig stellt sich eine Regeneration ein, die nicht ausreichend ist für eine dauerhaft gute Funktion der Extremität im Alltag. Hierbei ist aufgrund der Reinnervationsgeschwindigkeit der Nerven der Abstand von Nervenläsion und Zielmuskel von besonderer Bedeutung.1 Erfolgt die Vorstellung zur Beurteilung zu spät, was leider sehr häufig der Fall ist, können die Zielmuskeln durch Umbauvorgänge bereits irreversibel geschädigt sein.


3. Hier zeigt sich ein Neurom eines Digitalnervs, nach Bohrmaschinenverletzung mit 24 MHz untersucht. Der Nerv hat hier keine faszikuläre Struktur mehr, ist stark verdickt in der Nervenquerschnittsfläche (etwa um das 6Fache) und echoarm mit scharfer Begrenzung.
Die hier ermittelte Nervenquerschnittsfläche beträgt 6,7 mm2
4. Im Vergleich ein gesunder Nervus ischiadicus am mittleren Oberschenkel links, untersucht mit 18 MHz, und eine partielle Läsion mit Neurombildung rechts auf gleicher Höhe nach Verkehrsunfall eines jungen Mädchens.
Die hier ermittelten Nervenquerschnitsflächen betragen 26 mm2 auf der gesunden Seite und 62 mm2 auf der betroffenden Seite.
70 // VISIONS 31
5. Hier besteht eine hochgradige iatrogene Läsion des N. medianus nach Ellbogengelenksarthroskopie. Der Nerv zeigt rechts im Bild eine Neurombildung nach nahezu vollständiger Kontinuitätsunterbrechung. Lediglich einzelne Fasern am Rand waren noch erhalten.

6. Darstellung eines kutanen Nervs mittels 33MHzSonde im Querschnitt. Selbst bei diesem kleinen Nerv lässt sich die faszikuläre Struktur erkennen. Ebenso die scharfe Begrenzung und die Einbettung des Nervs in das umgebende Gewebe.
In diesem Fall der infrapatellare Ast des N. saphenus, ein bei operativen Eingriffen am Knie gefährdeter Nerv mit hohem Potenzial für chronische Schmerzen.



„Je höher die Auflösung des Ultraschallgerätes und Schallkopfes, desto sicherer können hier insbesondere intranervale Strukturen wie die Faszikel beurteilt werden.“
VISIONS 31 // 71 © 2021 C ANON MEDICAL SYSTEM S
Dr. med. Alexandra Borchert
Fazit
Der Nervenultraschall ist in der Diagnostik traumatischer peripherer Nervenverletzungen eine Methode, die sowohl hinsichtlich der Handhabung und RisikoNutzen-Konstellation für den Patienten als auch hinsichtlich ihrer Bedeutung für das Outcome der Betroffenen nicht mehr wegzudenken ist.
Ausblick
Es gibt rege Diskussionen darüber, wie groß die Zeitfenster einer noch als zielführend einzustufenden operativen Maßnahme nach Nerventrauma sind. Genauer: Es stellt sich die Frage, in welcher Konstellation auch eine spätere operative Intervention zur Verbesserung der Innervation gerechtfertigt ist, z. B. zwei Jahre nach Nervenläsion oder länger. In welchen Konstellationen profitieren Patienten hiervon? Wir kennen einzelne Fälle, in denen eine späte Intervention noch zu einer Verbesserung der Funktion führen konnte. Da sowohl operative Nervenersatzverfahren als auch bereits operative Explorationen mit Manipulation an den Hüllstrukturen eines Nervs mit einem Risiko verbunden sind, wünscht man sich hierfür weitere Orientierungshilfen.
Möglicherweise kann uns hier die Technik der Sonographie perspektivisch in die Hände spielen und z. B. in Analogie zu SMI Methoden bieten, die den intraneuralen axoplasmatischen Fluss innerhalb eines Nervs widerspiegeln. Stagniert dieser Fluss, wie bei einem Kompartmentsyndrom, kann eine Eröffnung der Hüllstruktur zur Wiederherstellung des intraneuralen axoplasmatischen Flusses eine weitere Verbesserung erreichen? Wir kennen diese Phänomene, auch nach inflammatorischen Läsionen. Hier wäre weitere Bildgebung eine Chance auf eine bessere Planung operativer Interventionen. //

7. Höhergradige Schädigung des R. superficialis N. radialis nach distaler Radiusfraktur und osteosynthetischer Versorgung mit Ausbildung eines Neuroms auf Höhe des Handgelenks, dargestellt mit 33 MHz.
Dr. Alexandra Borchert ist seit Anfang 2019 in eigener neurologischer Praxis in Aachen tätig.

Zuvor etablierte sie als Oberärztin die Nerven und Muskelsonographie in Berlin im AVK, wo sie das Neurophysiologische Labor leitete. Seit 2007 untersuchte sie zusammen mit Prof. Dr. Schilling in der Universitätsklinik Münster Kinder und Erwachsene systemisch mit dem Ultraschall, ermittelte Referenzwerte und baute die Spezialsprechstunde auf.
Sie ist als Tutorin tätig und zertifiziert durch DEGUM und DGKN.
Referenz:
1 Review: Nerve Ultrasound in Traumatic and Iatrogenic Peripheral Nerve Injury Juerd Wijntjes, Alexandra Borchert, Nens van Alfen, Diagnostics 2021, 11(1), 30: open access DOI: 10.3390/diagnostics11010030.

72 // VISIONS 31
Dr. Alexandra Borchert
Die Lupe für den diagnostischen Ultraschall



Active Matrix-Array-Sonden mit ultra-breitband Frequenzen bis 33 MHz. In Kombination mit Intelligent Dynamic Micro-Slice (iDMS) werden Strukturen im Submillimeterbereich aufgelöst.

Ultra-Wideband Linear i24LX8
Ultra-high Frequency Linear i33LX9


https://de.medical.canon




https://de.medical.canon Online-Fortbildungen Radiologie Campus. Die neue Veranstaltungsreihe von Canon.
Die Canon Online-Seminare Radiologie Campus sind kurzweilig und geben Ihnen einen gezielten Überblick über aktuelle und spannende Themen in der Radiologie.
NEU! Ab September online!
Die neuesten Termine und Themenbereiche finden Sie tagesaktuell auf unserer Seite www.radiologiecampus.de





















































 Abb. 1 a: biphasische Abdomen-CT, Canon Aquilion Prime, Rekonstruktion: AIDR 3D; DLP 1003,6 mGy × cm / 18,1 mSv.
Abb. 2 a: biphasische Abdomen-CT, Canon Aquilion Prime, Rekonstruktion: AIDR 3D; DLP 1003,6 mGy × cm / 18,1 mSv.
Abb. 1 b: biphasische Abdomen-CT, Canon Aquilion Prime, Rekonstruktion: AiCE; DLP 716,5 mGy × cm / 12,9 mSv.
Abb. 2 b: biphasische Abdomen-CT, Canon Aquilion Prime, Rekonstruktion: AiCE; DLP 716,5 mGy × cm / 12,9 mSv.
Oberbauchorgane.
Abb. 1 a: biphasische Abdomen-CT, Canon Aquilion Prime, Rekonstruktion: AIDR 3D; DLP 1003,6 mGy × cm / 18,1 mSv.
Abb. 2 a: biphasische Abdomen-CT, Canon Aquilion Prime, Rekonstruktion: AIDR 3D; DLP 1003,6 mGy × cm / 18,1 mSv.
Abb. 1 b: biphasische Abdomen-CT, Canon Aquilion Prime, Rekonstruktion: AiCE; DLP 716,5 mGy × cm / 12,9 mSv.
Abb. 2 b: biphasische Abdomen-CT, Canon Aquilion Prime, Rekonstruktion: AiCE; DLP 716,5 mGy × cm / 12,9 mSv.
Oberbauchorgane.

Abb. 5 a: Low-Dose-Thorax-CT, Canon Aquilion Prime SP, Rekonstruktion: AIDR 3D; DLP 115,8 mGy × cm / 2,1 mSv
Abb. 4 a: Low-Dose-Thorax-CT, Canon Aquilion ONE, Rekonstruktion: AIDR 3D; DLP 55,1 mGy × cm / 1,0 mSv
Abb. 5 b: dieselbe Untersuchung, Rekonstruktion: AiCE
Abb. 4 b: Low-Dose-Thorax-CT, Canon Aquilion Prime SP, Rekonstruktion: AiCE; DLP 65,7 mGy × cm / 1,2 mSv
Abb. 5 a: Low-Dose-Thorax-CT, Canon Aquilion Prime SP, Rekonstruktion: AIDR 3D; DLP 115,8 mGy × cm / 2,1 mSv
Abb. 4 a: Low-Dose-Thorax-CT, Canon Aquilion ONE, Rekonstruktion: AIDR 3D; DLP 55,1 mGy × cm / 1,0 mSv
Abb. 5 b: dieselbe Untersuchung, Rekonstruktion: AiCE
Abb. 4 b: Low-Dose-Thorax-CT, Canon Aquilion Prime SP, Rekonstruktion: AiCE; DLP 65,7 mGy × cm / 1,2 mSv




















 RCA Rechter Hauptstamm
Linker Hauptstamm
Peripherer RIVA (AHA Seg. 8 + 10)
Fall 2:
RIVA
RCX
RCA Rechter Hauptstamm
Linker Hauptstamm
Peripherer RIVA (AHA Seg. 8 + 10)
Fall 2:
RIVA
RCX
















































 Abb. 5 a + b: Hochaufgelöstes Bild des Hippocampus; 0,15 mm x 0,15 mm; 2 mm Schichtdicke; rechts mit AiCE-Rekonstruktion. Mit freundlicher Genehmigung des Unversitätsklinikums Bordeaux.
Abb. 6 a + b: Hochaufgelöstes Bild des Knies; 0,15 mm x 0,15 mm (interpoliert); 1 mm Schichtdicke; rechts mit AiCE-Rekonstruktion.
Abb. 5 a + b: Hochaufgelöstes Bild des Hippocampus; 0,15 mm x 0,15 mm; 2 mm Schichtdicke; rechts mit AiCE-Rekonstruktion. Mit freundlicher Genehmigung des Unversitätsklinikums Bordeaux.
Abb. 6 a + b: Hochaufgelöstes Bild des Knies; 0,15 mm x 0,15 mm (interpoliert); 1 mm Schichtdicke; rechts mit AiCE-Rekonstruktion.











































 Spindelförmig verdickte midportion Achillestendinopathie auf 10,6 mm ap-Durchmesser vs. 6,8 mm auf der gesunden Gegenseite.
Die Scherwellenelastographie zeigt die pathologische Elastizität mit 7,2 m/s (links) vs. 3,8 m/s (rechts).
Spindelförmig verdickte midportion Achillestendinopathie auf 10,6 mm ap-Durchmesser vs. 6,8 mm auf der gesunden Gegenseite.
Die Scherwellenelastographie zeigt die pathologische Elastizität mit 7,2 m/s (links) vs. 3,8 m/s (rechts).






























